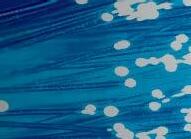

Rolls-Royce — powered by Singing River Electric — has completed a major investment in its Pascagoula site that will provide increased capabilities and capacity to support U.S. Navy programs.
A new 26,000-foot facility, with foundry and machining equipment provided by a U.S. Department of Defense DPA Title III grant, will increase the company’s ability to manufacture propellers and propulsor components for naval platforms.

Dan Rediger, Rolls-Royce Head of Naval Operations – Defense said: “We’re excited to complete a second major U.S. investment in our naval capabilities since 2020, with the opening of this new facility in Pascagoula, Mississippi. Rolls-Royce is proud to play a vital role in the shipbuilding supply chain and we remain committed to supporting the growing needs of the U.S. Navy with world-class, American-made products and services.”
Some of the first work to be delivered from the new facility will be fixed-pitch propellers for the U.S. Navy’s Constellation-class (FFG-62) guided missile frigate program. Last year, Rolls-Royce reached agreement with Fincantieri Marinette Marine to design and manufacture up to 40 propellers for the program.

Poultry farmers, state legislators, local government o cials, loggers, fuel retailers, energy utilities and utility regulators were all represented at an October roundtable to discuss the impact of high energy prices on farmers and businesses. Organized by national organization, the Consumer Energy Alliance (CEA), the purpose of the discussion was to learn about challenges in specific business sectors and to raise awareness about the linkage between high energy costs, access to energy, and energy policy at the state and federal levels.
Even though electric cooperatives have been hiring more ex-military, the energy sector still tends to fly under the radar for veterans.
The irony of this “awareness gap” is that there is near-universal agreement about the synergies between military service and the electric industry.
“Both have strong people with a sense of loyalty and duty in serving our community or country,” says National Rural Electric Cooperative Association Principal for Cybersecurity Ryan Newlon, who spent 20 years in the Missouri Army National Guard. “It blows my mind that they’re so similar.”
Over the past two years, there’s been a wave of veteran retirements from the energy industry, dropping their representation from 9.6% in 2019 to 8% in 2021, according to the latest Gaps in the Energy Careers report published by the Center for Energy Workforce Development.
Raising the energy industry’s profile among vets is especially critical at electric co-ops, where the pending retirement rate is particularly high, with some 35% of co-op employees expected to leave within the next six to 10
years, according to CEWD data.
NRECA Workforce Programs Manager Desiree Dunham says it’s essential that co-ops are seen as a viable option for all potential talent pipelines.
“Connecting with men and women transitioning out of the military and showing them the career options and how ideal a fit co-op work is will help coops with building a skilled and diverse workforce,” she says.
NRECA launched its Vets Power Us initiative, which Dunham leads, in 2020 to facilitate the connection between job-seeking veterans and co-op career opportunities. Co-ops can access resources to help recruitment e orts and provide information to veterans about jobs.







There are similar hiring initiatives throughout the energy industry, but veterans nevertheless are proving an elusive group to attract.



Advocates say it boils down to breaking down barriers, meeting the veterans where they are, creating awareness of energy jobs, and highlighting the similarities.
— Victoria A. Rocha. RE Magazine
Congressman Michael Guest led the discussion and listened to participants, like poultry farmers, who talked about how 70% energy cost increases have wiped out profits and added uncertainty to the future of their business.
“The rising cost of energy is leading to higher prices for everything — impacting families across our state as they struggle to purchase gas and groceries,” Guest said. “To combat these high costs, I am fighting for strong domestic energy policies through my work in Congress. I’m grateful for the opportunity to work with the Consumer Energy Alliance, the Mississippi Energy Institute, and other experts on these issues toward our common goal of bringing down energy costs and securing our nation’s energy independence.”
Some of the discussion was around federal energy policies advanced by the current administration that have resulted in less investment and growth in American oil and gas production during the postpandemic period.
As other places are dismantling their economies due to restrictive energy policies, Mississippi and other energy producing states should sell themselves as reliable energy states and raise awareness about the policies that result in abundant energy at a more a ordable cost.
The Christmas season is finally here. Most know it as the most wonderful season of all. It’s a time of giving and spreading joy. We associate it with family traditions and gathering with friends and loved ones.
But giving back reminds me of the many good things we have right here in our community and why it’s so important to spread the good as far as we can, especially to the non-profit organizations in our local area. I’m also reminded of how wonderful our community is and what a big impact we can have when we work together.
When you are a member of 4-County, you help us spread the good throughout the year. Through our 4-County Foundation, your donations help local non-profit organizations.
When you “round up” your monthly bill from 4-County and donate to this fund, you’re making a big di erence in peoples’ lives. You are helping to meet an immediate, critical need, but just as importantly, you are telling people that your co-op cares.
You’ve likely heard me say that the cooperative principle “concern for community” is part of 4-County’s DNA. It defines who we are as an organization. When we first brought electricity to this community over 85 years ago, the quality of life improved. And, today, we’re bringing our members high-speed internet service with FASTnet. But other things also need to be addressed and through the years, this co-op has been at the forefront of bringing improvements to the quality of life in this community. It’s why we created The 4-County Foundation. (See sidebar)
To date, with your help, we’ve collected over $1.8 million and awarded over $1.7 million back to local families and individuals through this program. Ninety-three percent of our members participate in our Operation Round Up program. And across the country, more than 350 electric co-ops have an Operation Round Up program, and together, we’ve raised millions for local communities. This shows that small donations from electric co-ops like ours, over time, can collectively make a big impact.
4-County also participates in the Electric Cooperative Youth Tour, where we take our community’s brightest young people to Washington, D.C. for a week-long immersion to experience democracy in action. (See story on page 16.) Ultimately, the larger community benefits from these programs because of you and your neighbors.
As a local cooperative, we have a stake in this community. It’s why we support our members and local organizations. We hope you will think of 4-County as more than your energy provider, but also as a catalyst for good in our community. For more information on the 4-County Foundation, call 1-800-431-1544.
I hope all our members have a joyous Christmas season. May it be merry and bright! Merry Christmas and Happy New Year from your 4-County family!


Seven area organizations received awards recently from the 4-County Electric Power Foundation. Over $48,000 was distributed at the October meeting.
Those receiving recent Foundation awards were:
• Chickasaw County Board of Supervisors $5,500 for first responder support
• Choctaw County High School $7,185 for robotics team start-up costs
• Frank Phillips YMCA $3,000 for Parkinsons/Adaptive Therapy equipment
• French Camp Observatory $4,800 for Planetarium programs
• Junior Auxiliary of Starkville $8,000 for food pantry support


• The Mission $10,000 to purchase security cameras for housing
• Noxubee County Historical Building $10,000 for museum maintenance
Since the Foundation’s inception in February 2015, over $1.7 million has been dispersed to organizations in 4-County’s service area.
4-County believes in helping the communities it serves. Since February 2015, participating 4-County members’ utility bills have been rounded up to the nearest dollar; a $125.78 bill, for example, becomes $126. Now, that’s an average of only 49 cents per member, per month. That may not seem like much. But when you multiply those contributions by the thousands of member participants, that’s a lot of pennies!
by Brian Clark CEO/General ManagerThe next foundation meeting is Dec.12. Applications must be received by Dec. 1. For more information on the 4-County Foundation, call 1-800-431-1544.
“Improving the quality of life for all those we touch.”
Who will be the leaders of tomorrow? For that answer, take a look at the children of today. And if the 2023 4-County Cooperative Youth Leaders contestants are a reflection of that statement, the future is a bright one, indeed.













Seventeen young leaders from the 4-County service area, selected as winners to represent their schools, competed in the Youth Leaders Program, Nov. 9 at the 4-County Corporate Center.



Four high school juniors were selected to represent the cooperative at the 2023 Cooperative Leaders Workshop, sponsored by the Electric Cooperatives of Mississippi, in Jackson March 1-3.
Averie Gundy, a student at French Camp Academy, was the first-place winner. Evelynn Stevens, a student at Choctaw County High School, was the second-place winner. There was a tie for third. Arianna Brown of New Hope High School and Mackenzie Murphy of Starkville each received third-place honors.


In addition to participating in the Youth Leadership Workshop, they will travel to Washington, D.C., for the National Rural Electric Cooperative Association’s Youth Tour of the Capital, June 18-23.



The 17 candidates competed for the opportunity to win the expense-paid trips. Nominated by his or her high school, each student completed an application reflecting school and extracurricular activities. The application also included several short essay questions. A panel of three judges a liated with the Electric Cooperatives of Mississippi interviewed each of the 17 students at 4-County’s Corporate Center Nov. 9.
The purpose of the local youth program is to provide leadership development and training opportunities for young 4-County members and to educate a future generation about the cooperative form of business.
Other students participating in the 4-County program, selected as winners for their respective schools, were Joseph Rollins of Eupora High School, Ti’Niya Townsend of Golden Triangle Early College High School, MacKenzie McCleod of Mississippi School for Math & Science, Riley Oglesby of Victory Christian Academy, McKaylan DeLoach of West Lowndes High School, Kaley Ballard of Caledonia High School, Patrick Doumit of Heritage Academy, Jeb Sisk of East Webster High School, Kyra Young of Columbus High School, Katie Thomas of Starkville Academy, Noah Brand of Oak Hill Academy, Anna Davis of Starkville High School, and Joshua Durr of Hebron Christian School.
Brad Barr, 4-County’s Youth Tour coordinator, applauded the e orts of all 17 candidates. “All of the candidates were outstanding. We can definitely look forward to a bright future if these young leaders are any indication. I believe they are. They were strong representatives of their families and schools,” Barr said.
Employees and members of 4-County Electric Power Association and FASTnet are working to make Christmas better and brighter for area children by taking part in the Toys for Tots program.
Toys for Tots, a charitable organization o ered through the U.S. Marine Corps Reserves, has maintained a partnership with 4-County the last 10 holiday seasons. Last year, employees and members dug deep and collected nearly 300 toys for distribution in 4-County’s service area.

“This is a great Christmas project,” said 4-County Communications Coordinator Brad Barr. “We’re always excited to team up with the Marine Corps Reserves Toys for Tots project. A lot of children identified by Toys for Tots wouldn’t have the same Christmas experience without the help of this charitable organization and organizations like 4-County.”



Toys for Tots drop-o boxes will be located in 4-County o ces this month through Dec. 14. “All we ask is that you drop o a new, unwrapped toy in one of the boxes located in the 4-County o ce nearest you,” Barr explained.
Again, the deadline for dropping o toys is Dec. 14. Toys for Tots personnel will pick up the items by the end of that day. Call Barr at 1-800-431-1544 for more information about the Toys for Tots project. (Note: Special arrangements to pick up toy donations can also be made by calling Brad.)
Consider purchasing LED lights, which use less energy and run cooler than traditional incandescent lights.
Never mount or support light strings in a way that might damage the cord’s insulation.
Make sure that cords are not pinched in doors, windows, or under heavy furniture, which could damage the cord’s insulation.
Always unplug electrical decorations before replacing bulbs or fuses.
Turn o all indoor and outdoor electrical decorations before leaving home or going to sleep.
OFF Source: Electrical Safety Foundation International




FASTnet continues to provide internet to its customers at a breakneck pace. In October, we installed 697 services, the most we’ve ever completed in one month. And we’re not stopping.



The 4-County Electric Power Association broadband subsidiary began service in October in the Lake Lowndes area. By the end of the year, according to FASTnet o cials, technicians should be installing service in all parts of Lowndes County. FASTnet should also begin serving its Prairie phase by early next year.






Although we’re moving quickly, some customers may still encounter a waiting period. That’s because FASTnet has a large

waiting list and it can only install so many services at a time. We appreciate everyone’s patience as we work to bring the service to them.


We’re also building out the mainline fiber to our final phases. Construction has started in the South Macon and Sturgis phases and will continue into Choctaw County. We hope to be installing services everywhere by late next year.
You can call us at 1-800-431-1544 for more information or to make a request for service. You can also visit our website at www.4cfastnet.com and go to the check availability page.
Two new employees have recently joined the 4-County Electric Power Association team.


Curtis Collier of French Camp has joined the team as a Journeyman Lineman. He began his initial cooperative career with 4-County in October 2016 and served four years as a Journeyman Lineman before leaving for a two-year stint as a Safety Instructor for the Electric Cooperatives of Mississippi. Curtis o cially returned to 4-County Oct. 31 as a Journeyman Lineman, working on Eric Yarbrough’s Corporate Center crew.
Curtis and his wife, Anna, have two children: Emma Kate, 4, and Dixon, 8 months.
His hobbies include “piddling” on the family’s 100-acre farm.
Welcome back to the 4-County team, Curtis!
Marquetta Clark of Starkville has joined the 4-County Electric Power Association team as a Consumer Services Representative.
She and her husband, Rodrigues, have eight children, ranging in age from 9 to 24. Prior to 4-County, she worked at Impressions Solutions in Columbus. In her spare time, she enjoys spending time with family, cooking, and traveling.
Welcome to the 4-County team, Marquetta!
Curtis Collier Marquetta Clark
In accordance with the laws of the State of Mississippi and the bylaws of the Association, three directors will be elected for three year terms. Members will elect two directors from Leake County, and one director from Attala County.


(a) It shall be the duty of the Board to appoint, not less than sixty (60) days nor more than ninety (90) days before the date of a meeting of the members at which Board members are to be elected, a Committee on Nominations consisting of three (3) members who shall be selected from the given areas from which Board members are to be elected so as to insure equitable representation. No existing Cooperative employees, agents, o cers, directors or known candidates for director, and close relatives (as hereinafter defined) or members of the same household of existing Cooperative employees, agents, o cers, directors or known candidates for director may serve on such committees. The committee shall receive and consider any suggestion as to nominees submitted in writing by members of the Cooperative. The committee, keeping in mind the principle of equitable representation, shall prepare a list of nominations for Board members, and submit its list to the Secretary not less than thirty (30) days nor more than sixty (60) days before the date of the annual meeting.

(b) Any fifty (50) or more members who are in good standing, are from the given area from which a Board member is to be elected, and acting together, may nominate a Director candidate for the area by petition. Any such petition for nomination must be submitted on a form designated and provided by the Cooperative. Each member signing such petition shall place thereon the date of signing, address, account number and service location of the member. Such nominations made by petition, if any, shall be delivered to the Secretary not less than forty-five (45) days nor more than sixty (60) days before the date of the annual meeting. Such nominations shall be posted by the Secretary at the same place where the list of nominations made by the
Committee on Nominations is posted. A member may not make more than one (1) nomination by petition for each vacancy. If a member signs more than one petition for a director vacancy, then the signature of the member bearing the latest date of signing by the member will be considered and any previously dated signature by the member on any other petition(s) will be deemed invalid, null and void. If a member signs more than one petition on the same date, all signatures of the member bearing the same date of signing will be deemed invalid, null and void. (c) The Secretary shall prepare and post at the principal o ce of the Cooperative at least twenty (20) days before the meeting a list of nominations for Board members. The Secretary shall be responsible for mailing with the notice of the meeting or separately, but at least ten (10) days before the date of the meeting, a statement of the number of Board members to be elected and the counties they will be elected from and represent, and the name and address of each of the candidates nominated by the Committee on Nominations or by petition.
A report from the Committee of Nominations and other annual meeting information will appear in the March issue of Today in Mississippi. As a member-owner of Central Electric Power Association, you have a right to participate in the annual meeting to hear the latest cooperative news and to elect the board of directors.
Mark your calendar for March 21, 2023 and plan to attend Central Electric’s annual meeting at the Carthage Coliseum on Highway 16 in Carthage.


 by Miranda Boutelle
by Miranda Boutelle
Winterizing is an important step to keep your home cozy and your bills low. These tried-and-true methods will ensure your home is sealed tight and ready for colder weather. I’ve also included tips that address common misconceptions.

You can raise the water temperature inside your home’s water pipes by 2 to 4 degrees by insulating, according to the U.S. Department of Energy (DOE). Insulating allows you to turn down the heat on your water heater, saving energy and money.
Start by insulating the pipes coming out of your water heater. If you have a gas water heater, keep pipe insulation at least 6 inches away from the flue. Insulate hot and cold water lines. The latter can prevent condensation and freezing pipes. Insulating your water heater can save 7% to 16% on water-heating costs, DOE says. Insulation kits are available at hardware stores. Don’t obstruct the pressure relief valve, thermostats, or access valves.
Air sealing and insulation are a great combination for minimizing home energy use. Insulation is like a warm sweater for your home, and air sealing is the wind breaker. All the cracks, gaps, and holes in a typical home can be like having a window open yearround. Air sealing eliminates those leaks. It can be done as a do-it-yourself project, or by a professional.

How can I keep my home warm while saving on my electric bill this winter?
Windows can be a source of drafts and wasted energy. Close windows tightly.
Add weatherstripping around windows to prevent warm air from escaping your home and caulk the gaps where the window trim meets the wall and the window frame. Add curtains to make the room feel warmer.
Storm windows are a lower-cost option for upgrading single-pane windows. They are available with low-emissivity coatings, which insulate better, and are available for installation either from the inside or outside of the window.
Through the years, I have heard a lot of debate about closing off rooms or parts of the home to save energy.
Best practices come down to the type of heat source. If you have a zonal heating system, where individual areas are controlled separately, you can close doors and only heat the areas you use. Examples of zonal systems are wall heaters, baseboard heat, hydronic radiant heat, radiators, and ductless heat pumps, also called mini-splits.
Keep areas with plumbing or water lines warm enough so pipes do not freeze.

If you have a central forced-air heating system, leave doors open to all heated areas. Closing doors and/or register dampers forces the system to work harder, uses more energy, and can shorten the life of heating equipment.

When I was little, my dad told me it was too cold to have a fire. I remember thinking that made no sense, but he was right.
We had an open, wood-burning fireplace — not a wood stove. A fireplace can draw the warm air out of the house, cooling it down, or causing your heating system to use more energy.

Your fireplace adds ambience to your home, but isn’t necessarily effective at heating it. If you have a wood-burning fireplace, close the damper when your fire is extinguished. An open damper in the winter is an easy exit for the air you paid to heat.
Adding tempered glass doors to a wood-burning fireplace can create an extra buffer between the cold outside and a cozy living space.
Some gas fireplaces require a damper to remain permanently open so gas can vent out of the home. Check the specifications of your unit to ensure safe operation.
Maintaining a clean filter in your furnace is one of the best ways to keep it running efficiently and prevent costly repairs. Check your furnace or ductless heat pump filter monthly during peak heating season.








FROM OUR CO-OP FAMILY TO YOURS, WISHING YOU A HAPPY HOLIDAY SEASON AND A JOYOUS NEW YEAR.

Central Electric Power Association will be closed Dec. 23 and 26 for Christmas and Jan. 2 for New Years.





To report an outage, please visit www.centralepa.com and click on Report An Outage, call 601-267-3043, or text the word OUT to 866-846-5671 if you are enrolled in the outage texting service. A dispatcher is on duty 24 hours a day, 7 days a week.

MS 38645














































by Abby Berry
Mind the thermostat. This is one of the easiest ways to manage your home energy use. We recommend setting your thermostat to 68 degrees (or lower) when you’re home. When you’re sleeping or away for an extended period of time, try setting it between 58 and 62 degrees; there’s no need to heat your home when you’re away, or sleeping and less active.
Button up your home. The Department of Energy estimates that air leaks account for 24% to 40% of the energy used for heating and cooling a home. Caulking and weather stripping around windows and doors are simple, cost-e ective ways to increase comfort and save energy. If you can feel drafts while standing near a window or door, it likely needs to be sealed.
Use window coverings wisely. Open blinds, drapes, or other window coverings during the day to allow natural sunlight in to warm your home. Close them at night to keep the cold, drafty air out. If you feel cold air around windows, consider hanging curtains or drapes in a thicker material; heavier window coverings can make a significant di erence in blocking cold outdoor air.
Consider your approach to appliance use. When combined, appliances and electronics account for a significant chunk of our home energy use, so assess how e ciently you’re using them. For example, if you’re running the dishwasher or clothes washer, only wash full loads. Look for electronic devices that consume energy even when they’re not in use, like phone chargers or game consoles. Every little bit helps, so unplug them to save energy.
Think outside the box. If you’re still feeling chilly at home, think of other ways to warm up — beyond dialing up the thermostat. Add layers of clothing, wear thick socks, and bundle up under blankets. You can even add layers to your home! If you have hard-surface flooring, consider purchasing an area rug to block cold air that leaks in through the floor.
Abby Berry writes on consumer and cooperative a airs for the National Rural Electric Cooperative Association.














held Nov. 1 at the new headquarters — 3355 Rudyard-Jonestown Road in Coahoma.


In addition to our members and friends, an invitation was extended to our local dignitaries as well as our sister and fellow co-op employees, managers, and department heads. These cooperatives have been instrumental in providing assistance to us through the years.

Everyone was graciously welcomed and served by the sta at CEPA. A guided tour of the facility also took place to share a glimpse of the new and improved building. The new headquarters is equipped with the necessary and essential tools needed to keep power flowing daily to our members.
We would like to extend a huge hand of appreciation to the experts who played a significant part in the building, planning, and construction of our facility.
We were also extremely proud and excited to welcome back and share some fellowship with many of our retirees. They were once a part of the driving force and glue to our cooperative and contributed more than four decades of their lives to the service of our members.
We want to send out a compassionate and heartfelt “Thank You” to sta , members, and friends who have played a role in reaching a strong and thriving 85 years of service.
 Association’s members and friends was
Association’s members and friends was





























Our o ces will be closed Friday, Dec. 23, and Monday, Dec. 26 in observance of Christmas. We will reopen on Tuesday, Dec. 27, 2022.
Our o ces will be closed Monday, Jan. 2 in observance of New Year’s Day. We will reopen on Tuesday, Jan. 3, 2023.

Have you ever received your energy bill and thought, “I wonder which appliances in my home are using the most energy?” Don’t worry – you’re not alone. A few years ago, after being away for a somewhat lengthy trip, I arrived home to a typical energy bill. I was surprised because I expected a lower bill after being away from home. This led me to an enlightening journey in search for answers.
My first set of answers came from browsing the Energy Information Administration’s (EIA) website, specifically the Residential Energy Consumption Survey. According to EIA, a typical U.S. home spends more than $2,000 annually on energy bills, and on average, more than half of household energy consumption is for just two energy end uses: space heating and air conditioning. Seeing this, I understood the importance of adjusting my thermostat while I’m away because it truly makes a di erence on our monthly bills.
I also learned that water heaters tend to be the third largest energy user at 13%, followed by lighting, which usually accounts for about 12.5% of the average energy bill.
Once I understood the factors driving my energy consumption, I was able to control them and save money by using helpful devices like smart thermostats, water heater controllers, and smart power strips.
Several factors a ect the amount of energy a household uses, including geographic location and climate, the number of people in the home, the type of home, and its physical characteristics. The e ciency of energyconsuming devices and the amount of time they are used also impact home energy consumption.
In addition to the steps noted below, consider using real-time energy monitors to help identify faulty appliances or other problems like a broken water heater that runs unnoticed for extended periods of time, leading to high energy bills.
With a little extra attention to how you use energy in your home, you’ll be well on your way to a path of energy savings — and lower energy bills.
Omotoso



Use ENERGY STAR®-rated appliances and devices.

Use appliances with e ciency in mind. Only wash full loads of clothes or dishes. When possible, cook with smaller, countertop appliances.
Replace old, ine cient equipment. If your air conditioner, or water heater is more than 10 years old, it is likely using a lot more energy than necessary. A newer model will save you money in the long run and help you avoid an inconvenient breakdown.
Set your thermostat accordingly to scale back heating or cooling when asleep or away. In the home and active, the Department of Energy recommends setting it to 78 degrees in the summer and 68 degrees in the winter.
Use energy e cient LED bulbs. They use 75% less energy than incandescent bulbs and last 25 times longer. Plug electronics into a smart power strip, which allows you to designate “always on” for devices that need to maintain network connection, while cutting power from devices like speakers and TVs when they are not in use.





















Merry Christmas! In this joyous and busy season, I want to say a heartfelt thank you to all Coast Electric members who participate in our Operation Round Up program. Last month, at our Annual Meeting, we announced a major milestone that I would like to celebrate with you. We started rounding up bills for participating members in December of 2018 and now, just four years later, your generosity has allowed us to distribute over $1 million in grants to charitable organizations that make a positive di erence in our community. One million dollars. Your spare change has done so much for the people of South Mississippi. This holiday season, when you look back over the past year, I hope you are proud of
your participation in Operation Round Up and of the di erence you are making for your friends and neighbors. Together, we are accomplishing great things, and I can’t wait to see what we do together in 2023!
by Ron Barnes President and CEOCoast Electric wants you to reduce your energy use and see savings on your energy costs. Each month, you will have an opportunity to register to win a prize that will help you reduce the energy consumption in your home. All you have to do is visit www.coastepa.com and fill out our entry form. It only takes a few seconds, and you could win a prize that helps you save!


We would like to thank all those who attended our Annual Meeting as well as those who registered by proxy. Your participation in our meeting and election process are critical to co-op success.
$6.2 million.


At Coast Electric’s Annual Meeting on Nov. 3, three members were elected as directors for Position Two and received the following votes:




Gil Arceneaux • 11,974
Teri Eaton • 11,974
Frank McClinton • 11,974
Congratulations to these members! We appreciate your dedication to serving your fellow Coast Electric members.
Coast Electric Power Association President and CEO Ron Barnes announced at the cooperative’s 2022 Annual Meeting that the cooperative will retire $6,229,069 in capital credits to its members, which is the largest retirement in company history. Checks are scheduled to be mailed to eligible current and former members in December. By the end of 2022, Coast Electric will have paid more than $87 million in capital credit retirements to current and former members.




Member-owned cooperatives are not-for-profit organizations operated for the benefit of their members. In general, if there are revenues from electric services in excess of operating costs and expenses, those funds are credited to a member’s capital account based on their patronage. Such funds, which are also called ‘capital credits,’ are the lifeblood that enables cooperatives to satisfy the future growth and power needs of its members. Capital credits represent a critical source of equity for Coast Electric. Since a cooperative’s members are also the people it serves, capital credits reflect each member’s ownership in, and contribution of capital to, the cooperative.

Each member is allocated capital credits based on how much energy they obtain from the cooperative. The more energy a member purchases, the greater the amount of capital credit allocated to the member’s account. At the end of each year, Coast Electric subtracts operating costs and expenses from operating revenue collected during the year. This di erence is called margins, which are allocated to the members on the basis of patronage.
Any member who has purchased electricity from Coast Electric during the time period being retired is eligible to receive a capital credit check. Checks will be mailed to the last address Coast Electric has on file. This is why it is important for former members to make sure we have your current address on file.

Members who have questions about their capital credit accounts, may visit https://coastepa.com/my-benefits/#capital-credits.
Coast
$1 million in
grants to local charities. “The success of Operation Round Up is measured in the number of residents that stay warm in the winter because they were able to pay their energy bill through our Share Your Blessings fund. It’s measured in the number of backpacks we fill with food and send home with kids on the weekend because they wouldn’t otherwise eat again until school on Monday and by the number of job seekers who receive job readiness training and now have a long-term way to provide for their families. It’s measured by the number of life-saving prescriptions filled for senior citizens who might normally have to choose between taking their medicine and eating. By every work of art that makes our community more beautiful and by every life saved because there was access to food and safe shelter.”
— Dr. Raymunda Barnes Coast Electric Community Trust Committee Chairman

At Coast Electric’s Annual Meeting in November, outgoing Community Trust Chairman Dr. Raymunda Barnes announced a major milestone in giving for Coast Electric’s Operation Round Up program. Since Coast Electric began rounding up participating members’ bills in December of 2018, more than $1 million has been invested into our community in the form of grants for charitable organizations that make our community a better place to live. That means Coast Electric members who participate in Operation Round Up are part of the most philanthropic organization on the Mississippi Gulf Coast.
Besides reaching more than $1 million in total grants, the Community Trust Committee also reviewed 46 grant applications and approved 26 of these for a total of $227,102 for this round of grants alone.
Dr. Barnes and his colleagues on the Community Trust Committee have dedicated four years to the Operation Round Up program to ensure cooperative members’ donations are going to worthy organizations that make a di erence in the lives of Hancock, Harrison and Pearl River County residents. While normally a three-year term, this committee wanted to stay on for an additional year since funds were diverted to our Share Your Blessings fund in 2020 to aid residents a ected by the pandemic.
“Our Community Trust Committee members have been a voice for our cooperative members through the Operation Round Up program,” said Janell Nolan, Coast Electric’s Director of Community Development. “They have dedicated their time, expertise and hearts to this program to make it something our members can be proud of. Under their leadership, we’ve made a di erence in so many lives. We thank them for taking on this role. I know the program will continue to thrive because of their contributions.”











































Mind the thermostat. This is one of the easiest ways to manage your home energy use. We recommend setting your thermostat to 68 degrees (or lower) when you’re home. When you’re sleeping or away for an extended period of time, try setting it between 58 and 62 degrees; there’s no need to heat your home when you’re away, or sleeping and less active.

Button up your home. The Department of Energy estimates that air leaks account for 24% to 40% of the energy used for heating and cooling a home. Caulking and weather stripping around windows and doors are simple, cost-e ective ways to increase comfort and save energy. If you can feel drafts while standing near a window or door, it likely needs to be sealed.
Use window coverings wisely. Open blinds, drapes, or other window coverings during the day to allow natural sunlight in to warm your home. Close them at night to keep the cold, drafty air out. If you feel cold air around windows, consider hanging curtains or drapes in a thicker material; heavier window coverings can make a significant di erence in blocking cold outdoor air.




Consider your approach to appliance use. When combined, appliances and electronics account for a significant chunk of our home energy use, so assess how e ciently you’re using them. For example, if you’re running the dishwasher or clothes washer, only wash full loads. Look for electronic devices that consume energy even when they’re not in use, like phone chargers or game consoles. Every little bit helps, so unplug them to save energy.
Think outside the box. If you’re still feeling chilly at home, think of other ways to warm up — beyond dialing up the thermostat. Add layers of clothing, wear thick socks, and bundle up under blankets. You can even add layers to your home! If you have hard-surface flooring, consider purchasing an area rug to block cold air that leaks in through the floor.


Abby Berry writes on consumer and cooperative a airs for the National Rural Electric Cooperative Association.



 by Miranda Boutelle
by Miranda Boutelle
Winterizing is an important step to keep your home cozy and your bills low. These tried-and-true methods will ensure your home is sealed tight and ready for colder weather. I’ve also included tips that address common misconceptions.

You can raise the water temperature inside your home’s water pipes by 2 to 4 degrees by insulating, according to the U.S. Department of Energy (DOE). Insulating allows you to turn down the heat on your water heater, saving energy and money.
Start by insulating the pipes coming out of your water heater. If you have a gas water heater, keep pipe insulation at least 6 inches away from the flue. Insulate hot and cold water lines. The latter can prevent condensation and freezing pipes. Insulating your water heater can save 7% to 16% on water-heating costs, DOE says. Insulation kits are available at hardware stores. Don’t obstruct the pressure relief valve, thermostats, or access valves.
Air sealing and insulation are a great combination for minimizing home energy use. Insulation is like a warm sweater for your home, and air sealing is the wind breaker. All the cracks, gaps, and holes in a typical home can be like having a window open yearround. Air sealing eliminates those leaks. It can be done as a do-it-yourself project, or by a professional.

How can I keep my home warm while saving on my electric bill this winter?
Windows can be a source of drafts and wasted energy. Close windows tightly.
Add weatherstripping around windows to prevent warm air from escaping your home and caulk the gaps where the window trim meets the wall and the window frame. Add curtains to make the room feel warmer.
Storm windows are a lower-cost option for upgrading single-pane windows. They are available with low-emissivity coatings, which insulate better, and are available for installation either from the inside or outside of the window.

Through the years, I have heard a lot of debate about closing off rooms or parts of the home to save energy.
Best practices come down to the type of heat source. If you have a zonal heating system, where individual areas are controlled separately, you can close doors and only heat the areas you use. Examples of zonal systems are wall heaters, baseboard heat, hydronic radiant heat, radiators, and ductless heat pumps, also called mini-splits.
Keep areas with plumbing or water lines warm enough so pipes do not freeze.
If you have a central forced-air heating system, leave doors open to all heated areas. Closing doors and/or register dampers forces the system to work harder, uses more energy, and can shorten the life of heating equipment.

When I was little, my dad told me it was too cold to have a fire. I remember thinking that made no sense, but he was right.
We had an open, wood-burning fireplace — not a wood stove. A fireplace can draw the warm air out of the house, cooling it down, or causing your heating system to use more energy.

Your fireplace adds ambience to your home, but isn’t necessarily effective at heating it. If you have a wood-burning fireplace, close the damper when your fire is extinguished. An open damper in the winter is an easy exit for the air you paid to heat.
Adding tempered glass doors to a wood-burning fireplace can create an extra buffer between the cold outside and a cozy living space.
Some gas fireplaces require a damper to remain permanently open so gas can vent out of the home. Check the specifications of your unit to ensure safe operation.
Maintaining a clean filter in your furnace is one of the best ways to keep it running efficiently and prevent costly repairs. Check your furnace or ductless heat pump filter monthly during peak heating season.
Miranda Boutelle is the vice president of operations and customer engagement at Efficiency Services Group in Oregon. Windows can be a source of drafts and wasted energy. Weatherstrip and close windows tightly to prevent warm air from escaping your home. Your fireplace adds ambience to your home but isn’t necessarily effective at heating it. If you have a wood-burning fireplace, close the damper when your fire is extinguished.Have you ever received your energy bill and thought, “I wonder which appliances in my home are using the most energy?” Don’t worry – you’re not alone. A few years ago, after being away for a somewhat lengthy trip, I arrived home to a typical energy bill. I was surprised because I expected a lower bill after being away from home. This led me to an enlightening journey in search for answers.
My first set of answers came from browsing the Energy Information Administration’s (EIA) website, specifically the Residential Energy Consumption Survey. According to EIA, a typical U.S. home spends more than $2,000 annually on energy bills, and on average, more than half of household energy consumption is for just two energy end uses: space heating and air conditioning. Seeing this, I understood the importance of adjusting my thermostat while I’m away because it truly makes a di erence on our monthly bills.
I also learned that water heaters tend to be the third largest energy user at 13%, followed by lighting, which usually accounts for about 12.5% of the average energy bill.
Once I understood the factors driving my energy consumption, I was able to control them and save money by using helpful devices like smart thermostats, water heater controllers, and smart power strips.


Several factors a ect the amount of energy a household uses, including geographic location and climate, the number of people in the home, the type of home, and its physical characteristics. The e ciency of energyconsuming devices and the amount of time they are used also impact home energy consumption.


In addition to the steps noted below, consider using real-time energy monitors to help identify faulty appliances or other problems like a broken water heater that runs unnoticed for extended periods of time, leading to high energy bills.
With a little extra attention to how you use energy in your home, you’ll be well on your way to a path of energy savings — and lower energy bills.
Set your thermostat accordingly to scale back heating or cooling when asleep or away. In the home and active, the Department of Energy recommends setting it to 78 degrees in the summer and 68 degrees in the winter.
Use energy e cient LED bulbs. They use 75% less energy than incandescent bulbs and last 25 times longer. Plug electronics into a smart power strip, which allows you to designate “always on” for devices that need to maintain network connection, while cutting power from devices like speakers and TVs when they are not in use.


















As we move into the holiday season, most of us look forward to spending time with our families and friends. But for most of us, the holidays also bring additional expenses. This can make the season hard to enjoy when money is short, and this year is probably more di cult than other years in recent memory because, as you know, everything is more expensive. We can’t help with most of those expenses, but this is the time of year when our members may see a credit on their power bill.
You have always heard us refer to you as members and not customers. That’s because Dixie Electric is a member-owned, not-for-profit cooperative, and we abide by seven cooperative principles, one of those being Member Economic Participation. But what does that mean? There are two parts to this answer.

First, you, as members, contribute equitably to the capital of the cooperative. In years where there are margins from electric services beyond operating costs and expenses, those funds are credited to your capital account based on the amount of electricity you use. They represent your equity ownership in the cooperative, similar to the equity you may have in your home. They are called capital credits because they provide a portion of the capital needed to purchase equipment and to build and operate the cooperative’s electrical distribution system. These funds reduce the need for loans and related expenses like interest to help lower costs, which benefits all members.



The second part deals with how and when capital credits are retired or returned to you. Each year, assuming the funds are available,
members receive a credit on their power bill in November or early December, which is typically when the annual capital credit retirement occurs. Dixie Electric has a long-standing history of retiring capital credits, and this year is no exception. The board of directors for Dixie Electric approved a retirement of just under $1 million to the members for 2022, which represents a full retirement of 1992 and a partial retirement of 2021. All told, Dixie Electric has retired more than $37.6 million over the life of the cooperative.

Your capital credit will appear as a line item on your power bill as a credit, and former members with inactive accounts will be issued a check. Capital credits are just one of many benefits of cooperative membership.


On behalf of our team at Dixie Electric I wish you and your family peace, joy, and prosperity this holiday season. It has been our honor to serve you this year.
by Randy Smith General ManagerDixie Electric held its annual meeting on Saturday, Oct. 22, in person and virtually at dixieepa.com. Opportunities for voting began online in late August and by mail-in balloting in September. With the new addition of push notifications to members, online voting increased this year by almost 500 votes. More than 5,600 members participated in the board elections this year, continuing a trend of strong voter participation.
For each vote cast or proxy submitted, Dixie Electric’s board of directors agreed to donate $1 to be divided equally among the Christian Food Mission in Laurel, Petal Children’s Task Force, and the Samaritan Closet and Pantry in Waynesboro. Each of these beneficiaries will receive a donation of $1,900.
At the annual meeting, Lucy Cooley and Sears Ward were re-elected to serve on the board of direc tors. General Manager Randy Smith gave a brief overview of the cooperative, including the progress of DE Fastlink. He also discussed the $1 million capital credit retirement and recapped our year of community service efforts.
Why aren’t there more candidates to choose from on the ballot?
Any member can seek election to the board of directors in the district where they reside by meeting the qualifications as prescribed in Dixie Electric’s ByLaws. We place the qualifications and instruc tions in Today in Mississippi, May through July. If you see a district with only one name on the ballot, it is because only one member qualified to be placed on the ballot in that district. Although there are criteria that, if not met by a potential candidate, could disqualify them from being placed on the ballot, that has not happened to date. Since the current method was adopted, no potential candidates who submitted applications have been disqualified by the Credentials and Election Committee. In the years where there has been only one candidate per district, that means that only one candidate submitted an application to be placed on the ballot. We have had as many as three candidates in a district on the ballot in two of the last three elections.

Why was my district not up for election this year?

Seven board directors represent seven districts and serve three-year terms, meaning they are re-elected every three years. Districts 1 and 5 were up for election in 2022, this year. Districts 2 and 7 will be up for election in 2023, and Districts 3, 4, and 6 will be up for election in 2024.

If the candidate is running unopposed, why does my vote matter?
Electric cooperatives are guided by seven cooperative principles, with one being Member Democratic Control. Even if there is only one candidate on the ballot, that candidate still has to be voted on by the membership. In addition, Dixie Electric must have at least 10 percent participation from its membership in order to meet the quorum requirements to hold an official annual meeting, regardless of the number of candidates running for election.


• Burrito Express
• Chili’s in Petal
• Cow & Coop’s
• Dickey’s BBQ Pit
• Jitters Co eehouse
• KaRazy Kones KaRock’s
• Lee’s Co ee & Tea
• Mi Casita Grill in Waynesboro
• Mi Casita Mexican Restaurant in Laurel
• Phillips Drive In
• Pizza Inn of Waynesboro
• Poppa’s Cajun Creamery
• Poppa’s Original Wharf Seafood

• Quickway Market, LLC
• Reyes Mexican Grill & Bar
• Sake Café
• Shug’s Cookie Dough & Candy Bar
• The Catfish Wagon Restaurant
• The Dinner Bell
• The Knight Butcher
• The Smokehouse of Laurel
• Walker’s Dairy Bar
• Zaxby’s of Petal
• A Service of Women’s Pavilion of South MS
• Core Nutrition and Wellness, LLC
• Ellis & Walters Dental Care
• Richard Williams at Wade’s
• Thompson’s Barber Shop
Doris Tanner’s Florist, Inc.
• Four Seasons Florist
• Randall Blake Florist & Gifts
• Allie’s on Magnolia
• Carter’s Jewelry of Petal
• City Home Center
• Epic Styles
• Gatlin’s Building Supply
• Heart & Sole Boutique
Miss Behavin
• Quarter Century
• Quinn Pharmacy & Gifts
• Rhinestone Ranch
• Rubies Home Furnishings

• Sassy Scrubs
Southern Lace Boutique
• The Boutique on Central
• The Cotton Boll
• The Pink Anchor
• Wells Pharmacy
• Windy Hollow Farms & Nursery
• 601 Graphics & Gear, LLC
• A1 Graphics
• B&C Mobile Homes
• Break-A-Way, Inc.
• C&C Welding
• Dayon Tree Service, Inc. H and S Construction
• Hall’s Welding Service, LLC
• Let’s Make Something Fabric Shop
• Michael Jordan Construction, LLC
• P and B Fencing
• Parker Automotive and Quick Lube
• Primerica, Inc.
• Sawmill Monogramming
• Southern Vinyl Blanks & More
• Vorteck Pest Control


As you begin to check o your holiday to-do list, be sure that practicing holiday electrical safety is at the top! Here are some practical electrical safety tips to make your holidays merry and bright.




As you prepare to deck those halls, first things first: carefully inspect your holiday decorations. Damaged sockets and loose or exposed wires can cause serious shock or start a fire.
Are you planning to string lights this holiday season? Never mount or support light strings in a way that might damage the cord’s insulation.
Speaking of lights, let the sugarplums safely dance through your head, and turn o those holiday lights before going to bed!
Dangling lights can be attractive to pets, so try and secure any hanging lines, and check for chewed or frayed wires.
Lastly, never overload electrical outlets or extension cords.



Dixie Electric would like to wish you a safe and happy holiday season. For more electrical safety tips, visit dixieepa.com.

Dixie Electric Power Association clears trees, limbs, and underbrush from the area around and below the power lines, called the right-of-way. Right-of-way clearing decreases the number of outages and reduces the risk of someone coming in contact with the power lines. Clearing the right-of-way protects individuals from the hazards of electricity and makes power restoration quicker and safer for both Dixie Electric’s members and personnel.
Clearing projects underway
Highway 588: Ellisville, Lowery Creek, Sandhill, Oak Bowery
West Laurel: Ellisville, Calhoun, Soso, Moss, Shady Grove
West Moselle: Moselle, Oak Bowery, Pine Grove, Airport





























As we approach the end of 2022 and look forward to 2023, I am excited about our future. Yes, 2022 has presented us with new challenges but as always, we rose to the challenge. From decreased supply and increased pricing for generation fuel, tight material deliveries and an ever-challenging work environment, the employees of East Mississippi Electric Power Association remain focused on our members.

The generation of electricity continues to present challenges. Many of the wholesale power generating systems are moving away from coal to natural gas for their generation fuel. While most have incorporated solar and wind into their generation mix, the go-to source for rapid spin-up of generation when needed is natural gas. The reduction in natural gas production in the United States caused a major increase in the pricing of this fuel.
At EMEPA, we continue to look for ways our members can o set the impact of this higher pricing. One option available to members is Time-of-Use rates. Time-of-Use rates allow members an opportunity to use energy at a reduced rate during periods of the day when energy cost less. By helping us reduce the total peak demand on the EMEPA system, savings can be achieved and passed along to these members.
We also o er Levelized Billing. A member choosing Levelized Billing will avoid the ups and downs of seasonal electricity bills. The amount the member pays each month is based on the 12-month average electricity use, keeping monthly payments about the same from month to month.
Additionally, by using our EMEPA app, you can receive daily text messages and a history graph of your energy use. I use this option to help know when use at my home is rising. I can then decide if the weather is causing the change in power use, or if I may have something in my home causing the change. Maybe I have a hot water heater element stuck on or a heat strip and air conditioning running together.
Recently, a fellow manager of another electric cooperative in our state told me a story about how he used their power use graph to solve a member’s high-bill questions. The member was questioning why his power bill had risen so much, and his power use graph showed a substantial increase starting at 7:30 each night continuing through 2 a.m. The member believed this was a metering issue. During a visit to the home to review the electrical loads, the manager discovered the member had purchased a new electric car and was charging the car each night. This was the reason for the increased power use.
Along with increasing wholesale power costs, we have seen a dramatic increase in material costs this year. Some of the hardware we use to build and maintain the 5,700 miles of distribution lines has tripled. The increased pricing along with tightening supply chains have been a challenge. Resourceful planning, reuse of retired materials and proven relationships with vendors benefit our members greatly.
We continue to see a tight workforce. Thankfully, EMEPA continues to retain a dedicated and highly-trained workforce capable of providing the service you have come to expect. We know you depend on us to deliver the services you need to empower your lives.
As we begin 2023, be assured we remain focused on our members’ needs and thank you for your continued encouragement and support.
East Mississippi Electric Power Association’s Board of Directors is pleased to announce the retirement of capital credits for the year 1992 totaling $2,222,221.56.





























As a not-for-profit electric cooperative, we belong to the communities we serve, so any excess revenues are shared back with the members. EMEPA plans our rate structure to provide the lowest possible rates for our members throughout the year without excess after operational expenses are paid. However, any operating margins that do remain are allocated to members receiving service during the year. These margins are called capital credits.
EMEPA uses capital credits to invest in the operations of the cooperative, purchasing bucket trucks, poles and wire, among other items. This reduces the need for loans and related expenses and helps to keep power costs low, which benefits all members. The amount retired to members is decided by the Board of Directors on a 30-year rotation and depends on EMEPA’s financial condition and strategic plan for growth and operations.
This is just one way we are making a cooperative di erence in service to you and our community. If you have any questions concerning this return, please give us a call at 601-581-8600.
















In a two-day competition, that began with Cooperative University and concluded with an interview session, three students out of 25 high school students were chosen to represent Magnolia Electric Power in the Electric Cooperatives of Mississippi (ECM), Youth Leadership Workshop in Jackson in March 2023 and the National Youth Leadership trip to Washington D.C. in June 2023.




Twenty-five students were invited to attend the local competition. After the first day, at Cooperative University where the students were judged on leadership skills, 13 students moved forward in the competition to the interview round.

“The 25 nominees who began the competition were selected by their school counselors from the schools in the Magnolia Electric Power service area,” said
Lucy Shell, Magnolia Electric Manager of Member Services and Communications.
“Fifty percent of the participant’s score comes from Cooperative University and the other 50 percent comes from their interview held the second day,” she said.
Following the interview process, three students scored high and were selected to attend the Leadership Seminar in Jackson and the trip to Washington D.C.




The top three choices by the judges over the two day period were: Brice Peeples of West Lincoln High School, Isabella Clark of McComb High School and Maggie Sheppard of Brookhaven High School

Peeples, Clark, and Sheppard will represent Magnolia Electric Power on both trips and have a chance to compete to be a delegate for the National Youth Leadership Council and win a $1,000 scholarship.

During the state youth workshop, students will tour the Mississippi State Capitol, meet with legislators, and visit the legislative galleries where they will see debates on legislation. They will learn about electric cooperatives, hear dynamic speakers, and take part in several group exercises aimed at building cooperation, trust, and leadership skills. Then, Peeples, Clark, and Sheppard will travel to Washington D.C. in June to tour the nation’s capital.
A nominee is chosen by their school counselor based on leadership qualities and community service. Also, a nominee’s parents or guardians must be a member of Magnolia Electric Power.
Shell added, “Each year, we tell our nominees that they should know that they are already winners when they come in the door because they were chosen by their schools as leaders in their communities,” Shell said. “Their dedication and commitment to make the world better is already being noticed.”




After a two-year hiatus due to Covid-19, the 2022 Magnolia Electric Power Cooperative Youth Leaders program came back strong with 25 young leaders from across MEP’s service area competing to win a trip to a leadership workshop in Jackson and a week-long, all-expense-paid trip to Washington D.C.
The MEP Cooperative Youth Leaders program invited 25 nominees to the MEP headquarters for the competition that was held on October 27 and 28. Twenty-four students, along with their parents and a few school o cials attended the workshop.
“Cooperative University is a one-day event which included: Youth Tour Overview, Magnolia Electric Power Overview, Meet a Lineman, Get-ToKnow-You Session, and a talk from our State Legislators,” said Manager of Member Services and Communications Lucy Shell. “We also included a ‘Leadership’ learning time and a learning session on how electricity gets to your home with our ‘Generation and Transmission’ talk followed by an activity.”
“The program is geared to teach the future leaders of our numerous local communities a little bit about the cooperative business model and work on their leadership skills, even at this first level,” Shell said. “We try to bring education along with fun leadership games to the students who attend.”
“We were excited to have seven of our state legislators take time from their busy schedules to come and talk with our students,” Shell said. “The students listened as Senators Kelvin Butler and Jason Barrett; and Representatives Angela Cockerham, Becky Currie, Vince Mangold, Sam Mimms and Daryl Porter, spoke to them and then gave them a question and answer time.”
The group had lunch, which was followed by more leadership training, a chance to “Meet a Lineman” and then a tour of our Operations Department and a chance to see MEP’s up-to-date technology, Shell said.

Magnolia Electric Power General Manager Darrell Smith gave a warm welcome to all the participants at the beginning of MEP’s Cooperative University as he emphasized how the nominees were already being looked at as leaders at their schools.
Other speakers included: Shell, MEP retiree Lineman/Serviceman Tony Martin, MEP Engineer Perry Clark, Cooperative Energy representative Tonya Williamson, and Chris Alexander, Member Services Coordinator at Electric Cooperatives of Mississippi (ECM).
Those who qualified to attend Cooperative University were: Beaudalaire Kerr, South Pike; Braden Bairfield, Brookhaven; Braxton Martin, Franklin Co.; Brice Peeples, West Lincoln; Brody Ray Taggart, Amite School Center; Carmen Lambert, Brookhaven Academy; Chandler Gilmore, Salem; Drew Berryhill, Franklin Co.; Emily Guy, Columbia Academy; Ethan DiGiovanni, Columbia Academy; Gracie Williams, Enterprise; Isabella Clark, McComb; Jacey Frazier, Bogue Chitto; Jerrod Nations, Enterprise; Kaitlyn Hughes, Lawrence Co.; Kayla Mcgee, South Pike; Key’Niee Smith, Salem; Leah Mallette, Parklane; Madelyn Grace Spring, Amite School Center; Maggie Jones, North Pike; Maggie Sheppard, Brookhaven; Mallory Martin, Brookhaven Academy; Max Welch-Dick, North Pike; Preslee Rushing, West Lincoln; and Taylor Jackson, Bogue Chitto.
Parents of the school nominee and counselors/o cials are also invited to attend the day and many of the parents come and learn at the event, too.
The students were judged during Cooperative University and at the conclusion of the event, 13 students moved forward in the competition to the interview round.

















FROM OUR CO-OP FAMILY TO YOURS, WISHING YOU A HAPPY HOLIDAY SEASON AND A JOYOUS NEW YEAR.







The Magnolia Electric Power business o ce will be closed beginning at 11 a.m. on Friday, Dec. 23, and will be closed Dec. 26 and 27 for Christmas. The business o ce will also be closed Jan. 2 for the New Years holiday.
To report a power outage or an emergency, call 601-684-4011 or use the SmartHub app. MEP Linemen will be on call.











































 by Abby Berry
by Abby Berry
We all have our favorite season. Some people love crisp, cool weather, and bundling up under a favorite blanket, while others prefer the warm temperatures summer brings and all fun outdoor activities that go with it. But there’s one thing we can all agree on: high winter bills are never fun. Your electric co-op is here to help you find ways to manage your home energy use and keep winter bills in check.
Mind the thermostat. This is one of the easiest ways to manage your home energy use. We recommend setting your thermostat to 68 degrees (or lower) when you’re home. When you’re sleeping or away for an extended period of time, try setting it between 58 and 62 degrees; there’s no need to heat your home when you’re away, or sleeping and less active.
Button up your home. The Department of Energy estimates that air leaks account for 24% to 40% of the energy used for heating and cooling a home. Caulking and weather stripping around windows and doors are simple, cost-e ective ways to increase comfort and save energy. If you can feel drafts while standing near a window or door, it likely needs to be sealed.
Use window coverings wisely. Open blinds, drapes, or other window coverings during the day to allow natural sunlight in to warm your home. Close them at night to keep the cold, drafty air out. If you feel cold air around windows, consider hanging curtains or drapes in a thicker material; heavier window coverings can make a significant di erence in blocking cold outdoor air.
Consider your approach to appliance use. When combined, appliances and electronics account for a significant chunk of our home energy use, so assess how e ciently you’re using them. For example, if you’re running the dishwasher or clothes washer, only wash full loads. Look for electronic devices that consume energy even when they’re not in use, like phone chargers or game consoles. Every little bit helps, so unplug them to save energy.
Think outside the box. If you’re still feeling chilly at home, think of other ways to warm up — beyond dialing up the thermostat. Add layers of clothing, wear thick socks, and bundle up under blankets. You can even add layers to your home! If you have hard-surface flooring, consider purchasing an area rug to block cold air that leaks in through the floor.
Abby Berry writes on consumer and cooperative a airs for the National Rural Electric Cooperative Association.



 by Miranda Boutelle
by Miranda Boutelle
Winterizing is an important step to keep your home cozy and your bills low. These tried-and-true methods will ensure your home is sealed tight and ready for colder weather. I’ve also included tips that address common misconceptions.

You can raise the water temperature inside your home’s water pipes by 2 to 4 degrees by insulating, according to the U.S. Department of Energy (DOE). Insulating allows you to turn down the heat on your water heater, saving energy and money.
Start by insulating the pipes coming out of your water heater. If you have a gas water heater, keep pipe insulation at least 6 inches away from the flue. Insulate hot and cold water lines. The latter can prevent condensation and freezing pipes. Insulating your water heater can save 7% to 16% on water-heating costs, DOE says. Insulation kits are available at hardware stores. Don’t obstruct the pressure relief valve, thermostats, or access valves.
Air sealing and insulation are a great combination for minimizing home energy use. Insulation is like a warm sweater for your home, and air sealing is the wind breaker. All the cracks, gaps, and holes in a typical home can be like having a window open yearround. Air sealing eliminates those leaks. It can be done as a do-it-yourself project, or by a professional.

How can I keep my home warm while saving on my electric bill this winter?
Windows can be a source of drafts and wasted energy. Close windows tightly.
Add weatherstripping around windows to prevent warm air from escaping your home and caulk the gaps where the window trim meets the wall and the window frame. Add curtains to make the room feel warmer.
Storm windows are a lower-cost option for upgrading single-pane windows. They are available with low-emissivity coatings, which insulate better, and are available for installation either from the inside or outside of the window.
Through the years, I have heard a lot of debate about closing off rooms or parts of the home to save energy.
Best practices come down to the type of heat source. If you have a zonal heating system, where individual areas are controlled separately, you can close doors and only heat the areas you use. Examples of zonal systems are wall heaters, baseboard heat, hydronic radiant heat, radiators, and ductless heat pumps, also called mini-splits.
Keep areas with plumbing or water lines warm enough so pipes do not freeze.

If you have a central forced-air heating system, leave doors open to all heated areas. Closing doors and/or register dampers forces the system to work harder, uses more energy, and can shorten the life of heating equipment.

When I was little, my dad told me it was too cold to have a fire. I remember thinking that made no sense, but he was right.
We had an open, wood-burning fireplace — not a wood stove. A fireplace can draw the warm air out of the house, cooling it down, or causing your heating system to use more energy.

Your fireplace adds ambience to your home, but isn’t necessarily effective at heating it. If you have a wood-burning fireplace, close the damper when your fire is extinguished. An open damper in the winter is an easy exit for the air you paid to heat.
Adding tempered glass doors to a wood-burning fireplace can create an extra buffer between the cold outside and a cozy living space.
Some gas fireplaces require a damper to remain permanently open so gas can vent out of the home. Check the specifications of your unit to ensure safe operation.
Maintaining a clean filter in your furnace is one of the best ways to keep it running efficiently and prevent costly repairs. Check your furnace or ductless heat pump filter monthly during peak heating season.
Have you ever received your energy bill and thought, “I wonder which appliances in my home are using the most energy?” Don’t worry – you’re not alone. A few years ago, after being away for a somewhat lengthy trip, I arrived home to a typical energy bill. I was surprised because I expected a lower bill after being away from home. This led me to an enlightening journey in search for answers.
My first set of answers came from browsing the Energy Information Administration’s (EIA) website, specifically the Residential Energy Consumption Survey. According to EIA, a typical U.S. home spends more than $2,000 annually on energy bills, and on average, more than half of household energy consumption is for just two energy end uses: space heating and air conditioning. Seeing this, I understood the importance of adjusting my thermostat while I’m away because it truly makes a di erence on our monthly bills.
I also learned that water heaters tend to be the third largest energy user at 13%, followed by lighting, which usually accounts for about 12.5% of the average energy bill.
Once I understood the factors driving my energy consumption, I was able to control them and save money by using helpful devices like smart thermostats, water heater controllers, and smart power strips.
Several factors a ect the amount of energy a household uses, including geographic location and climate, the number of people in the home, the type of home, and its physical characteristics. The e ciency of energyconsuming devices and the amount of time they are used also impact home energy consumption.
In addition to the steps noted below, consider using real-time energy monitors to help identify faulty appliances or other problems like a broken water heater that runs unnoticed for extended periods of time, leading to high energy bills.
With a little extra attention to how you use energy in your home, you’ll be well on your way to a path of energy savings — and lower energy bills.
Use ENERGY STAR®-rated appliances and devices.




Use appliances with e ciency in mind. Only wash full loads of clothes or dishes. When possible, cook with smaller, countertop appliances.
Replace old, ine cient equipment. If your air conditioner, or water heater is more than 10 years old, it is likely using a lot more energy than necessary. A newer model will save you money in the long run and help you avoid an inconvenient breakdown.
Set your thermostat accordingly to scale back heating or cooling when asleep or away. In the home and active, the Department of Energy recommends setting it to 78 degrees in the summer and 68 degrees in the winter.
Use energy e cient LED bulbs. They use 75% less energy than incandescent bulbs and last 25 times longer. Plug electronics into a smart power strip, which allows you to designate “always on” for devices that need to maintain network connection, while cutting power from devices like speakers and TVs when they are not in use.
As we put Thanksgiving behind us and enter the last month of the year, I often like to reflect on the previous 11 months as I prepare for the upcoming 12.
This past year presented continued challenges. Early February brought our community a substantial ice storm accompanied with extremely cold temperatures. Due in part to our enhanced tree trimming program, an outage that a ected neighboring utilities for days and weeks was limited to 40 hours, even with minimal thaw. Spring storms also brought similar outage results.
As temperatures reached record highs in the summer, so did the cost of fuels used to generate electricity. This combination drove electricity rates to their highest prices ever. Fortunately, reliability wasn’t an issue as our distribution system performed at its best during these peaks.













We’ve seen extreme heat, extreme cold, supply chain issues, inflationary costs, and labor challenges throughout this year. Another thing that Northcentral experienced was an exemplary safety record, priority number one.














Now let’s look ahead to the many opportunities the upcoming year holds for our community.



Merry Christmas. Stay safe.

 by Kevin Doddridge General Manager/CEO
by Kevin Doddridge General Manager/CEO

Spending an entire career at work with the same company is rarely heard of these days. Workers only spend an average of 3.7 years with a private-sector employer, according to the Bureau of Labor Statistics. At that rate, an employee may change jobs as many as 10 times over their career!


Paul “Rip” Connell is one of the rare exceptions to those statistics. On August 1, 2022, Connell retired from Northcentral, 31 years from the o cial date that he started as an apprentice lineman. We say, “o cial date,” but Connell worked summers before that as a parttime laborer for Northcentral.
It’s safe to say that loyalty means something to Connell. Over his long career, Connell was not only loyal to the cooperative and his crews, but also the Northcentral members that he served. “Co-op employees are the best. From the time that you walk through the door to apply for service until the meter is set, everyone is striving to see that the member receives great service,” he said.
He spent the latter part of his career as our Overhead Construction Superintendent. Virtually every line worker at Northcentral has either worked with or trained under Paul Connell as some point in their career. “Over my career, I was able to see this industry totally do a 180 in many aspects. Early on, safety was not to the top priority, but it is today,” said Connell.
As a lineman and superintendent, Connell experienced everything from restoration e orts during Hurricane Katrina to serious injuries of fellow employees. His dedication to his co-workers and service to Northcentral members was unfailing. Reflecting on his career, he says, “I have been very fortunate to work alongside some great folks that really took pride in their job and instilled that in me. Being a lineman to me, if done right, is one of the toughest jobs out there but also one of the most rewarding. The places I have been able to go and
the people and communities that we were able to help in times of need is the most rewarding.”
“The unique thing about him is that he is always thinking about the next step, not only for the next workday, but also months down the road. He was always planning and preparing,” said Director of Construction Darin Farley.
Retirement from Northcentral doesn’t mean that Connell is hanging up his toolbelt though. His reputation for doing the job safely and “the right way,” will carry on in a new role as instructor for the Utility Line Worker program at Northwest Mississippi Community College. The new position as an instructor helps feed his passion for leading young adults into a rewarding career in the utility industry. “Paul has always been a dedicated and well-respected employee at Northcentral. It’s quite admirable to see him retire and move on to give back to the industry,” said Northcentral General Manager and CEO Kevin Doddridge.
As an avid outdoorsman, Connell now has more time to enjoy hunting with friends and his wife, Leah. They will be able to spend more time at their second home in the mountains of Colorado, which he built himself with the help of many friends. For years, Connell has been heavily involved as Chair for the Mississippi Chapter of the Rocky Mountain Elk Foundation.
Friends, family, and Northcentral employees and retirees recently celebrated his career with a reception where old stories were shared and well wishes were given for a new and exciting chapter ahead. Connell summed it up saying, “Even though there were some tough days, honestly the old saying is true. If you love what you do, you will never work a day in your life.”
Thank you, Rip, for your years of dedicated service and contribution to our cooperative!


 Connell is congratulated by Kevin Doddridge.
Connell worked alongside Darin Farley his entire career.
Connell is congratulated by Kevin Doddridge.
Connell worked alongside Darin Farley his entire career.




The 72nd Annual Meeting of the members of Northcentral Electric Cooperative convened on Oct. 26, 2022, at 2 p.m., in their auditorium at 4600 Northcentral Way in Olive Branch.


Northcentral Board President Pat Woods welcomed those attending and called the meeting to order. Pastor Douglas Bell of CrossPointe Church was called upon to give an invocation. The minutes of the 2021 Annual Meeting were then read by Board Attorney James Woods.
There were 29,499 notices mailed to the membership on Sept. 29, 2022. Pursuant to the Cooperative’s Bylaws, it would take 5%, or 1,475 members, personally present or through proxies for the requirements of a quorum. Rita Hobbs, chairperson of the Cooperative’s Election Committee, reported that a quorum had been met.
Northcentral General Manager and CEO Kevin Doddridge presented the 2022 Annual Report for the Cooperative. Doddridge then addressed questions from the floor of those attending.
Hobbs then confirmed that the voting had ended, and the meeting was recessed while the Election Committee tallied the ballots.
District 3 Director Phil Lachaussee and District 5 Director Jerry Nichols were nominated by the members of their respective districts to run for re-election to the board and were uncontested. The board seat for District 7 was vacant due to the resignation of Director Joan Childress on August 25, 2022. Kimberly Gordon was nominated by the members of District 7 and was uncontested in the election. All nominations were certified by a meeting of the Elections and Credentials Committee on Sept. 20, 2022.
The meeting reconvened, and the Election Committee announced they were ready to report the count of the ballots for the election of directors.
Hobbs presented the election results as follows: In District 3, Phil Lachaussee received 1,808 votes; For District 5, Jerry Nichols received 1,811 votes; and in District 7, Kimberly Gordon received 1,808 votes. Therefore, Mr. Lachaussee, Mr. Nichols, and Mrs. Gordon were all elected for three-year terms.
There was no further business to come before the meeting, and the meeting was adjourned.


You can raise the water temperature inside your home’s water pipes by 2 to 4 degrees by insulating, according to the U.S. Department of Energy (DOE). Insulating allows you to turn down the heat on your water heater, saving energy and money.
Start by insulating the pipes coming out of your water heater. If you have a gas water heater, keep pipe insulation at least 6 inches away from the flue. Insulate hot and cold water lines. The latter can prevent condensation and freezing pipes. Insulating your water heater can save 7% to 16% on water-heating costs, DOE says. Insulation kits are available at hardware stores. Don’t obstruct the pressure relief valve, thermostats, or access valves.
Air sealing and insulation are a great combination for minimizing home energy use. Insulation is like a warm sweater for your home, and air sealing is the wind breaker. All the cracks, gaps, and holes in a typical home can be like having a window open year-round. Air sealing eliminates those leaks. It can be done as a do-it-yourself project, or by a professional.
Windows can be a source of drafts and wasted energy. Close windows tightly.
Add weatherstripping around windows to prevent warm air from escaping your home and caulk the gaps where the window trim meets the wall and the window frame. Add curtains to make the room feel warmer.
Storm windows are a lower-cost option for upgrading single-pane windows. They are available with low-emissivity coatings, which insulate better, and are available for installation either from the inside or outside of the window.
Maintaining a clean filter in your furnace is one of the best ways to keep it running e ciently and prevent costly repairs. Check your furnace or ductless heat pump filter monthly during peak heating season.
Winterizing is an important step to keep your home cozy and your bills low. These tried-and-true methods will ensure your home is sealed tight and ready for colder weather. I’ve also included tips that address common misconceptions.
Through the years, I have heard a lot of debate about closing o rooms or parts of the home to save energy.
Best practices come down to the type of heat source. If you have a zonal heating system, where individual areas are controlled separately, you can close doors and only heat the areas you use. Examples of zonal systems are wall heaters, baseboard heat, hydronic radiant heat, radiators, and ductless heat pumps, also called mini-splits.
Keep areas with plumbing or water lines warm enough so pipes do not freeze.
If you have a central forced-air heating system, leave doors open to all heated areas. Closing doors and/or register dampers forces the system to work harder, uses more energy, and can shorten the life of heating equipment.
When I was little, my dad told me it was too cold to have a fire. I remember thinking that made no sense, but he was right.
We had an open, wood-burning fireplace — not a wood stove. A fireplace can draw the warm air out of the house, cooling it down, or causing your heating system to use more energy.
Your fireplace adds ambience to your home, but isn’t necessarily e ective at heating it. If you have a wood-burning fireplace, close the damper when your fire is extinguished. An open damper in the winter is an easy exit for the air you paid to heat.
Adding tempered glass doors to a wood-burning fireplace can create an extra bu er between the cold outside and a cozy living space.
Some gas fireplaces require a damper to remain permanently open so gas can vent out of the home. Check the specifications of your unit to ensure safe operation.
Miranda Boutelle is the vice president of operations and customer engagement at Efficiency Services Group in Oregon.






For over 35 years, Pearl River Valley Electric has sent students on a life-changing trip to Washington, D.C. through the Electric Cooperatives of Mississippi’s Cooperative Youth Leaders program. On the trip, students from across Mississippi, picked for their outstanding leadership abilities, visit monuments, the U.S. Capitol, and the White House. Except for two cancelled years due to the pandemic, this trip has served as a hallmark for what electric cooperatives can do to inspire our youth and our communities.



The first step in the cooperative program is PRVEPA’s Cooperative University, which is held at the National Guard Armory in Columbia. Cooperative University is a one-day event where each school is represented by two students. The day consists of speakers, games, and various demonstrations. This year, speakers included representatives from Cooperative Energy, past leadership program students, and local legislators.






“The program has helped so many students realize a dream of traveling to see our nation’s capital,” said Leif Munkel, manager of marketing, communications, and member services. “For many students, the trip to






Washington, D.C. is an eye-opening experience and exposes them up to a much larger world.”


This year, 23 students from 12 schools sent students to the Cooperative University on Oct. 11. Judges interviewed all 23 students and chose two winners. This year’s winners are Lana Bishop from Stone High School, and Mateo Rouhbakhsh from Sacred Heart Catholic School.

Lana is the daughter of Donald and Tova Bishop. She is active in Beta Club, volleyball, and basketball. Recently, she helped register new voters to pass the Stone High School bond referendum which will build a new high school and athletic stadium.



Mateo is the son of Rambod and Darcy Rouhbackhsh. He is active in Beta Club, and is a member of National Honor Society and Mu Alpha Theta. He has also been active with the Make-A-Wish Foundation and is a volunteer coach for youth soccer.
Lana and Mateo will join thousands of other students from around the country in June to attend the Youth Tour in Washington, D.C. There, they will have the opportunity to meet their legislators, tour the U.S. Capitol, and take in other site seeing.

Alayna
Shanmukha
Lana
Georgia
Addison
Trenidy
Caleb
Heidi
Haven
Terriona
Mateo
Molly
Khallada
Kelby
Zarria Adams • Je Davis High School Atla • Oak Grove High School Bishop • Stone High School Anne Blackwell • Sumrall High School Coleman • Presbyterian Chrisitan Davis Jr. • Lamar Chrisitan Dubois • Columbia Academy Hanberry • Lamar Chrisitan Kyara Hendricks • East Marion Olivia Holford • Presbyterian Chrisitan Alana Holmes • West Marion Genevieve Kuehn • Sacred Heart Gracie Ladner • Purvis High School Adam Lambert • East Marion Brooke McKissack • Stone High School Maren Mills • Oak Grove High School Moree • Columbia High School O’Neal • Sumrall High School Reese • Je Davis High School Rouhbakhsh • Sacred Heart Sauls • Columbia Academy Varnado • West Marion Wingo • Purvis High SchoolWhat a difference a year has made for customers of PearlComm Fiber and members of Pearl River Valley Electric.

This time last year, crews were working to hang fiber in areas around Foxworth and Columbia. Now, PearlComm is connecting customers daily to the fastest high-speed internet in our service territory. Beginning in March, PearlComm connected its first customer in the Foxworth area and since that time has swiftly added additional milestones throughout the year.


In June, PearlComm celebrated its 500th customer and in August reached 1,000 customers. By the end of the summer, the fiber company had opened all Phase 1 areas around Foxworth, Columbia, and South Columbia. Beginning in the fall, areas around Maxie began customer installations. PearlComm currently boasts nearly 2,500 customers. This is amazing progress.
As I write this column, contractors for PearlComm are working as fast as possible to bring high-speed fiber internet to newly opened areas around Maxie and Wiggins. Currently, over 60 crews are working on fiber builds, drop constructions to homes, and in-home installations. As the build has progressed, PearlComm has steadily increased inhome installations and averages around 95 to 100 a week.
The combined efforts of Pearl River Valley Electric and PearlComm Fiber over the last couple of years has led to
this rapid deployment of fiber, however, the installations are only a small part of the entire plan. On average, it takes between 13 and 30 weeks to complete fiber builds in an area. The process begins with make-ready engineering which is the planning phase. Next, comes make-ready construction which includes the replacement of poles to make sure the existing infrastructure can support the fiber build. After the make-ready construction is complete, the installation of the fiber lines begins along with fiber splicing. Once these steps are completed, a crew installs the fiber drop to the home and then prepares for the inside installation of the router.

I know there is plenty of excitement and anticipation surrounding the project, and we want to keep our membership updated regarding our fiber build. The accompanying map on the next page shows the detailed plan of PearlComm’s fiber build, along with tentative dates for when construction and sign-ups are scheduled to occur. Currently, PearlComm plans to start connecting areas in blue on the map soon with future areas opening for installations throughout 2023.
As an electric cooperative, it is important that we are active in our communities, and this fiber project is one way to better the lives of our members and improve the future of our service territory. According to most surveys, Mississippi is ranked near the bottom among states with access to
high-speed internet. This is simply unacceptable, and I am proud that PRVEPA and its subsidiary PearlComm Fiber along with 17 other cooperatives across the state are leading the way connecting rural areas to high-speed fiber.
Remember, if you have not already pre-registered at pearlcommfiber.net, we encourage you to let us know you are interested in the service! Pre-registration is the easiest way to get notifications and service updates sent directly to your email when internet becomes available in your area; but preregistration does not automatically subscribe you to service.

Lastly, I would like to thank the many PRVEPA employees that have worked behind the scenes to make this fiber build a reality. Without their hard work and dedication, PearlComm Fiber would not exist. We appreciate your continued patience as PearlComm Fiber works to connect our service territory to high-speed fiber internet.
 by Matthew Ware
Manager
CEO/General
by Matthew Ware
Manager
CEO/General


















serves utilities in rural America, Pearl River Valley Electric has distributed grants to area volunteer fire departments and local food pantries.
Helping our communities succeed is an objective of all electric cooperatives, and CoBank’s Sharing Success program helps fulfill that goal. The program allows banking members, such as PRVEPA, to apply for grants which provide matching funds to help nonprofit organizations.
Pearl River Valley Electric chose two food pantries and two volunteer fire departments to receive funds. The Northcentral Volunteer Fire Department and the Pineburr Volunteer Fire Department plan to use their donations for essential lifesaving

and the Lamar Baptist Mission Center will buy food, clothes, and household items for their pantries.


“We o er resources for approximately 1,000 families a year and we try to provide them with an entire week’s worth of food when they come in for assistance,” said Dr. Danny Henderson, associational missions director for Lamar Baptist Mission Center. “Donations such as this grant from PRVEPA help to keep our essential food items stocked in our pantry so families don’t go hungry.”
Pearl River Valley Electric plans to continue doing charitable programs throughout the next year, which will beneficial to our members and their communities.




















































 by Jennifer Johnson
by Jennifer Johnson
Spending time on a lake can o er an opportunity to catch food for a meal, or time to relax and unwind from the stress of a hard week. PEPA member Steve Poindexter has found another reason to enjoy lake life – searching for driftwood to repurpose into unique creations.
A few years ago when he was o work for back surgery, Poindexter and his wife Cathy went into a “junk” store shortly before Christmas. He said he noticed someone had painted faces on pieces of the wood, and that gave Poindexter an idea: “I decided to carve Santas and give them to friends and family as gifts.”
He keeps truckloads of driftwood in his shed, allowing it to dry. Once the pieces are ready, Poindexter takes a look at each piece and sorts and separates it before he starts carving. He said he can make five Santas on a good day.



“Most of my carving is by hand. I keep a box of pocket knives that I’ve collected through the years. I use those a lot. I work on the faces, and then see how much space I have for the hat and body. Then I paint them and cover them with a wash mixture to keep that old look.”
Poindexter said he has cut and painted signs shaped like pumpkins, angels, and other items but the driftwood Santas are still his favorite. He’s even created Christmas ornament Santas from the driftwood. His creations are available for sale exclusively at Created Designs by Tammy in the Banner community on 9W.
As a young man, Poindexter worked in a grocery with the man who would become his father-in-law. When he met Cathy, he chuckled and said, “It was love at first sight for her.”
Later, Poindexter worked as a truck driver and drove for 40 years. He recalled “living with a trucker’s atlas” in the days before GPS. He
said he never had a chargeable accident, but he did see a lot of bad wrecks in his travels.
When he started having problems with his legs, he started working as a short-haul driver. He came o the road in 2002. He took a part-time job working for Calhoun County Sheri Greg Pollan as a police escort and a jailer. He worked for eight years as the jail administrator in Calhoun County. About a year ago, he took a baili job at the Calhoun County Courthouse but he’s never looked back at full time work. “I always enjoyed the work, but I never wanted to be the one who died as soon as they finally quit work.”
His wife Cathy works as a registered nurse in Oxford, and she plans to join Poindexter in retirement in a few years. They’ve been married 43 years.
For now, Poindexter is enjoying life, spending time with Cathy, their children and grandchildren, working his part-time job, actively working as a deacon in his church, and searching for more driftwood to complete his beloved Christmas project.
INGREDIENTS

10 oz white baking chocolate, or substitute white bark candy coating (see note)
3 cups heavy whipping cream, or regular whipping cream
1/2 can sweetened condensed milk
1 cup sugar
ICING
8 oz white baking chocolate, or substitute white bark candy coating (see note)
1/2 can sweetened condensed milk
2 tbsp whole milk, or more if needed for thinning mixture
1 oz white or semi-sweet chocolate morsels for garnish, if desired
Note:
1 cup whole milk
2 large whole eggs
8 large egg yolks
1 loaf white sliced bread
White bark vanilla candy coating or white chocolate morsels may be substituted for the white baking chocolate as a cost-saving measure with no noticeable difference in the taste. These may take a little more time to dissolve into liquid form.
Bread Pudding preparation:
Peel the crust from the bread slices and discard crust and end slices (the crust and end pieces can be saved to make homemade croutons for salads). Break the peeled white bread slices into smaller pieces and place in a 9” x 13” heat-treated glass baking dish.
In a double boiler, blend 10 ounces of white baking chocolate, 3 cups heavy or regular whipping cream, and a half can of sweetened condensed milk until mixture is completely liquid, but do not overheat. In a separate bowl, thoroughly blend 1 cup sugar, 1 cup whole milk, 2 whole eggs, and 8 egg yolks with mixer or whisk. Pour melted chocolate, cream/condensed milk mixture into mixing bowl with the egg/ milk/sugar mixture, and stir together. Pour the entire mixture onto the bread pieces in the 9 x 13 dish. Spoon the bread around until each piece is thoroughly saturated. Cover the baking dish with foil and bake at 275 to 300 degrees for one hour (oven temperatures may vary from oven to oven). Remove the foil and continue baking at 275 to 300 degrees for an additional 20 minutes to bring crust to a light golden color. Do not exceed either baking times, as correct temperature and cooking times are very important. It is important not to overcook. Remove from oven for 5 minutes and allow the center of the bread pudding to fall. A nice rim should form around the edge to contain the icing.
Icing preparation:
In a double boiler, melt 8 ounces of white baking chocolate with half a can of sweetened condensed milk, and only as much whole milk as needed to thin the mixture and make the icing somewhat liquid. Pour the melted icing over the bread pudding. Just before serving, garnish with white or semi-sweet chocolate morsels if desired. Served best while still warm from the oven, or microwave a cold 2” x 2” square for approximately 25 seconds.



For more information, call 601-947-4211 or 228-497-1313. SRE is an equal opportunity employer and provider.


To say 2022 has been challenging would be an understatement. Similar to what you have experienced at your homes over the past year, Singing River Electric has seen significant cost increases associated with materials, equipment, contract labor, and fuel. Scarce materials and high demand are part of a 40-year inflation high according to the Federal Reserve Bank, resulting in increased costs of business. For example, the price of a pole mount transformer used to provide electric service to a member home more than doubled over the past two years. The cost of a conductor for a threephase distribution line went up more than $15,000 per mile of line. In addition to inflated material costs, increased fuel prices have led to higher freight costs, higher contractor expenses, and additional costs for Singing River Electric employees to build and maintain our electric distribution system.

The rise in costs, combined with the existing supply chain issues, created an even greater challenge for your cooperative. Ramifications of the COVID-19 pandemic continued to cripple the nation’s supply chain system, decreasing the supply of raw materials and finished goods at a time when demand remained steady or even grew. To combat
the situation, Singing River Electric took a proactive approach to navigating the supply chain system by increasing the levels of items with longer lead times and placing orders well in advance for future projects. Singing River Electric’s strong relationships with suppliers have been a key advantage while procuring items necessary for providing reliable electric service to members. We are told supply chain disruptions may be here for a while longer. In the meantime, Singing River Electric will remain proactive in procuring materials, using creative decision making, maintaining vendor relationships, and praying Mother Nature is kind to us.
As a result of these challenges, Singing River Electric began a cost-of-service study last month to guide your cooperative in making sure funds are available so we can continue providing the safest and most reliable service to our members. We will obtain and review the results in the coming weeks.


Even with the many challenges experienced this past year, our employees continue to step up and provide the level of service our membership has come to expect. On behalf of the Singing River Electric family, I wish you a blessed Merry Christmas and a Happy New Year.
This holiday season, consider replacing older light strings with new Energy Star LED lights. They use 75 percent less energy than traditional incandescents and come in a variety of styles and colors for both inside and outside use. In fact, the energy used to light just one incandescent bulb can power two 24-foot strings of LED lights.

You can save even further by installing a timer for outdoor holiday lighting and decorations. Program the timer to turn on in the evenings and to turn o when you go to bed.
There’s also the safety benefit. Energy Star decorative LED holiday lighting is cool to the touch, which reduces the risk of fire.
For more information, visit singingriver.com and energystar.gov. Happy Holidays.
Merry, bright, and e cient holiday lightingGeneral Manager and CEO Brian Hughey

and block harmful apps, websites
Call us today at 877-272-6611 to add the Ultimate Wi-Fi Experience bundle.






SR Connect is delivering lightning-fast, fiber internet. Our most recent fiber opening is in SRE’s Harleston substation area. Call 877-272-6611 to sign up! Scan the QR code to search your address and view full-size maps of all fiber areas.
Visit singingriverconnect.com/signup to view full size maps.













Don’t like to wait on hold? Neither do we. Text a Singing River Electric member service representative (MSR) at 228591-9166. We will return your text and help resolve your issue or answer your inquiry. You can also text OUT to 601-947-1744 to report a power outage.






As of November 2022, SRE members were automatically enrolled in outage texting with


the cell phone number listed on their account. Members must have a mobile number on file to use outage texting because the system locates their account information with the number. Phone numbers and other contact information can be updated using the SmartHub mobile app, by texting a MSR, or by calling 601-947-4211 or any SRE o ce.
Our o ces will be closed Dec. 23 and 26 in honor of the Christmas holidays and Jan. 2 for the New Year’s holiday. Dispatchers will be on duty for emergencies and power outages. Use your SmartHub app to see billing information, make payments and see a live outage map.
singingriver.com/ SmartHub



SRE’s board of directors approved the retirement of more than $2 million in SRE capital credits to the membership for the year 1996. Cooperative Energy also retired $1.5 million in credits to SRE members for the year 1992 and partial returns for the years 2007, 2008 and 2009.
Capital credits less than $300 will be credited on December member bills. Credits greater than $300 will be mailed to SRE active members as a check. Visit singingriver.com/capital-credits for additional information.

and
Neighbors Helping Neighbors (NHN) Community Grants help Singing River Electric merge e orts with the hard work of those within our communities.
Since the program’s inception in 2001, $333,842.12 has been awarded to local non-profits in local communities.
George County School District resource o cers have needed gear and equipment after receiving a $2,500 Singing River Electric Neighbors Helping Neighbors Community Grant.

Funds from the grant purchased laptop computers, reflective vests, handcu s, firearm holsters, and other items for the three newly hired district resource o cers. The school district serves more than 4,100 students at eight schools and has a goal of providing quality education in a safe and secure atmosphere.
“We are grateful for the Singing River Electric grant program. It’s allowed us to provide our o cers the tools needed to protect not only our students and sta but also our community,” said Caleb Davis, Chief of the George County School District Police Department.
For more information on SRE NHN Community Grants and how to apply, visit singingriver.com/my-community. Grants for up to $2,500 are awarded to nonprofits in SRE’s service area three times a year in January, May, and September.
Round up your electric bill and help a neighbor in need this holiday season and year round. It’s easy! Simply check the NHN Energy Assistance box on your bill payment stub, sign up using the SmartHub app on any mobile device, go online and visit singingriver.com/give-joy or call any SRE o ce and request to be enrolled in Neighbors Helping Neighbors Energy Assistance giving.
Donations average only $6 per year and yet bridge the gap for the elderly and those needing a helping hand.























Time passes so quickly and it’s hard to believe Christmas is already upon us. This time of year brings colder temperatures, more entertaining, family gatherings, and, of course, more cooking. All these things can contribute to higher electric bills. Still, if you carefully monitor your usage, you can reduce your consumption and your cost.
Southern Pine has ways to help you take control of the things you can. The “99 Ways to Save” booklet, available on our website, is full of ideas about winterizing your home, reducing your usage, and making your home operate more e ciently. It’s a fantastic tool, and while every tip may not apply to you, I know you will learn some great ideas for e ciency.
Southern Pine also o ers free home energy audits. If you have concerns about your home’s energy usage, I encourage you to request a home energy audit and a Southern Pine employee will contact you to set up a time to visit your home. During the energy audit, we will identify areas where you can improve e ciency, thus helping you lower your energy use and reducing your energy bill.
I also hope everyone will sign up for the new MyPower mobile app if you haven’t already. Through the MyPower mobile app, you can easily
manage your account, pay your bill, report outages, and more. Knowing when you consume more power and quickly adjusting can impact your bill. Get your account information at your fingertips by downloading the app today.

Controlling what you can and reducing costs can help you enjoy the holidays by alleviating some of the financial stress that often comes with the added expenses of the season. Rest assured that we will continue to bring the power reliably, safely, and a ordably.
Merry Christmas from your friends at Southern Pine!



















Whether you’ve already decked your halls or you’re just getting started, there’s still time to incorporate energy savings into your holiday décor planning.

If you haven’t strung your twinkle lights, be sure to use LED light strands. LEDs consume far less energy than incandescent lights and they can last 40 holiday seasons. They’re also safer because they’re made with epoxy lenses, not glass, making them more resistant to breaking — and they’re cool to the touch, so no burnt fingers!




If you missed Santa’s memo about energy-saving LEDs and your holiday lights are already up, you can still save on lighting costs. All you need is a programmable light timer. Most models cost between $10 to $25 and can be purchased through online retailers like Amazon or at big box stores like Lowe’s or Wal-Mart. With a light timer, you can easily program when you want your holiday lights turned on and o , which will save you time, money, and energy. If you’re using a timer for exterior lighting, make sure it’s weatherproof and intended for outdoor use.
If Clark Griswold’s décor style is a bit much for your taste, consider a more natural approach. Many Christmas tree farms, and even retailers like Lowe’s and Home Depot, give away greenery clippings from recently trimmed trees. With a little twine, extra ornaments, and sparkly ribbon, you can create beautiful garlands and wreaths to hang over your front door or windows. To add extra twinkle at night, you can install solar-powered spotlights to illuminate your new (essentially free!) greenery. Solar spotlights can vary in price, but you should be able to purchase a quality set of four for about $30 — and because they run on natural energy from the sun, there’s no additional cost to your energy bill.
The holiday air reminds me of unforgettable memories of my early childhood. These cherished memories of family and traditions are what make the holidays sweet.
Christmas has held a special place in my heart for as long as I can remember. I am sure my friends and family can attest to the number of times I say “I can’t wait for Christmas” in a week. Maybe it is the season’s magic or because I was born just a few days before Christmas. I believe that the foundation my family created, built my a nity for Christmas.
My fondest memories of Christmas come from the time spent every Christmas Eve at my great-grandparent’s house, a modest, warm home in the countryside of Seminary. The McDaniel clan used to have lunch every Sunday at their house. Ours was a large family, so not everyone could always make it on Sundays, but Christmas was di erent. Christmas Eve was the one day that the entire family would come together. Over 50 of us would pile into the house and on the front porch. The sweet scent of cinnamon was in the air, and the savory snacks, beautifully presented along the wooden table, would soon be devoured. We would sit in the dining area of the tiny house that shouldn’t have been able to hold even half the people there, and we’d open presents. My great-grandparents wore constant smiles, always showing the joy that seeing us all together brought.
Of all the pieces that come together to form my Christmas memories, it’s not the presents or the food that stand out the most. It was the pure joy that came from being together. Happiness came from watching the smile on my mother’s face, catching up on the lives of my cousins, and simply soaking in the pleasure that being together brought us.
I remember Christmas Eve communion at my Nana’s church and coming back home to have dinner in our home with my grandma, nana, aunts, uncles, and cousins. We’d play Dirty Santa and then unwrap the annual Christmas pajamas. Christmas pajamas are the best! They seem cozier and warmer than any other pajamas of the year. After all the fuss died down and everyone had gone home to wait for the jolly old man, my brother and I would pile onto our parents’ bed. We’d whisper back and forth in the cramped queen until the sugar plum fairies coaxed us to sleep.
The next morning, we’d race down the hallway, filled with anticipation and excitement. We couldn’t wait to see the three presents we got from Santa. My parents always said we got three presents from Santa because Jesus got three presents. After opening gifts from Mama and Daddy, we’d rush to get ready and go to my Nana’s house for the best breakfast of the year and more family time. On Christmas morning at my Nana’s, we ate on the good China — only the best for a day so special.
Of all the pieces that come together to form my Christmas memories, it’s not the presents or the food that stand out the most. It was the pure joy that came from being together. Happiness came from watching the smile on my mother’s face, catching up on the lives of my cousins, and simply soaking in the pleasure that being together brought us.








1 ½ lbs. sausage (mix hot/mild)
1 tablespoons salt
9 eggs
2 cups grated cheddar cheese
3 cups milk



3 slices bread, crumbled
1 ½ teaspoons dried mustard
Cook and drain sausage. Mix with all other ingredients and pour into a 9X10 (I spray cooking spray on the pan for easy clean up). Refrigerate overnight. Bake for one hour on 350 degrees, uncovered.
by Becky Williamson1 8 oz. block cream cheese

½ to 1 cup powdered sugar (to taste)
1 container of Marzetti’s carmel dip


1 package of milk chocolate heath brickle
1 box sliced Granny Smith apples Slice several Granny Smith apples and preserve them to avoid turning.
Mix cream cheese and powdered sugar. Spread on to the bottom of a serving dish, leaving approximately a 1 to 1 ½ inch border. Spread the caramel dip on top. Cover with the brickle. This can be made ahead and refrigerated. When ready to serve, place sliced apples around the edge of the dip. You can also garnish the center with a couple of apple slices. Enjoy!
Matson Recipe by Tim Brown1 pound loaf of French bread
1 quart half and half or milk (minus 2-3 tsp for the sauce)
2 cups of sugar
1 teaspoon vanilla
3 eggs

½ cup raisins (optional)
1 teaspoon cinnamon
1 tablespoon sugar
1 stick of butter

1 box Baker’s white chocolate
1 cup powdered sugar
1 stick of butter
1 teaspoon vanilla
2-3 teaspoons half and half (from above)

Preheat oven to 350 degrees. Slice bread about 1 inch thick. Tear or cut the bread slices in approximately 1-2 inch pieces. Place in 13x9 baking dish. If you want to add raisins, add them under the bread. Mix half and half, eggs, sugar, and vanilla in a medium bowl, and pour over bread. Slice one stick of butter and place on top of the bread; then, sprinkle the sugar and cinnamon over the bread and butter. Bake at 350 degrees for 45-50 minutes until golden brown and bubbly.
Prepare the sauce by melting the white chocolate and butter over very low heat until smooth. Add the powdered sugar, vanilla, and half and half. Mix all ingredients until smooth (this may take a while). Pour sauce over the warm pudding.
2 cups self-rising flour (I prefer Martha White)
1 cup buttermilk (Don’t use reduced fat buttermilk. Biscuits are not supposed to be healthy.)
1⁄3 stick of butter (melted and put aside)
1 tablespoon sugar ½ cup of Crisco shortening
Preheat oven to 390 degrees. Place flour in a mixing bowl and add Crisco. Using two dinner knives, cut the grease into the flour. This is done by using the cutting edge of one knife against the flat blade of the second knife. Once the chunks of grease have gotten too small for the knives to be e ective, use a flour mixing whisk to complete cutting in the flour. Using the whisk significantly cuts down the time and e ort required to cut the grease into the flour. The consistency of the mixture should have a resemblance to sand. Add sugar to the mixture and add 1 cup of buttermilk. Thoroughly blend buttermilk into the mixture to finish composing the biscuit dough. If the mixture is too moist, add just a touch of flour. If mixture is too dry, add a touch of buttermilk. Place a handful of flour into an additional bowl. Prepare a standard baking pan with Crisco or cooking spray. Rub flour onto palms of your hands to keep dough from sticking to your hands. Take a portion of the dough (enough to make a ball about 3 inches in diameter) and place it in the bowl containing additional flour. Turn the dough over so that the entire portion is coated in flour. This procedure makes the dough much easier to roll into a ball and it keeps the dough from sticking to your hands. Roll the dough into a ball, flatten to about 4 to 4.5 inches and place on baking pan. Repeat and you should end up with 10-12 biscuits. Bake for approximately 12 minutes. To check and see if your biscuits are done baking, lift one up with a fork to see if underside is light brown. Once done, cut an X into top of each biscuit, apply melted butter with brush, and broil for two minutes to brown the tops.
P.O.












If you’re looking for ways to save energy and money in your home, check out the new Energy Resource Center available on Southwest Electric’s website at southwestelectric.coop/energy-calculators/. These fun, interactive tools help you zero in on where you can save the most – and fast!
Here’s what you will find in the Energy Resource Center:

Allows you to conduct a virtual assessment of your home. This quick calculator provides an estimated breakdown of your energy use and costs by heating, cooling, water heating, refrigeration, lighting and appliances. Learn how much you can save in each area.
Appliance Calculator
Calculates the cost of running appliances. For example, you can compare the cost of an oven versus a toaster oven.
TV Calculator
Compares di erent types of television operating costs.
Lighting Calculator Shows you savings for simple and easy lighting improvements.
In addition, you’ll find a complete Residential Energy Library where you can explore how your home uses energy and an Interactive Energy Home that allows you to tour a virtual home with cut-aways showing the best ways to save.





Southwest Electric held its 6th annual Cooperative University on Wednesday, November 9, at Macedonia Baptist Church in Lincoln County. Seventeen students from nine schools competed to become the 2023 representatives for Southwest Electric. The students had a full day of learning about electricity, the history of rural electric cooperatives and the cooperative business model, as well as hearing from state legislators. They had hands-on experience with a serviceman and a meter technician talking about their work and the tools they use, and had an opportunity to view a hybrid vehicle. Out-oftown judges chose a smaller group of students to return November 10 for an interview. This is the 35th year that Southwest Electric has participated in the Cooperative Youth Leaders program administered by the Electric Cooperatives of Mississippi.







The following students participated in Southwest Electric’s 2022 Cooperative University:
Gabrelle Bailey, Natchez High School
Kimori Bailey, Natchez Early College Academy
Samuel Bandy, Brookhaven Academy
KyJameonne Bingham, Je erson County High School
Price Chance, Brookhaven High School
Conner Cunningham, Loyd Star Attendance Center
Reagan Fortenberry, Brookhaven Academy
Alaina Hughes, Natchez High School
Ava McDonald, Adams County Christian School
Jason Miller, Franklin County High School
Ava Randall, Wilkinson County Christian Academy
Cylenthia Reed, Natchez Early College Academy
Blair Rutland, Adams County Christian School
Brayden Rutland, Loyd Star Attendance Center
Karradyn Suddeth, Je erson County High School
Aliyah Watkins, Brookhaven High School
Clay Whitehead, Wilkinson County Christian Academy
Our o ce will be closed on Dec. 23 and 26 for Christmas and Jan. 2 for New Year’s Day.
If you experience an outage or emergency, please report it on the SmartHub app or call 800-287-8564.
Dispatchers will remain on duty and crews will be on call throughout the holidays.















Ensure a merry and bright holiday season by safely maintaining your tree with the following tips.

Inspect lights
Examine extension cords and lights for signs of damage. Frayed electric cords should be discarded.
Make sure your tree is at least three feet away from any heat source like an airduct, fireplace or space heater.
Carefully inspect all electric decorations before you use them. Cracked or damaged sockets and/or loose or exposed wires can cause serious shock or start a fire.
Check the water level daily to ensure your tree stays hydrated. Some trees require up to a gallon of water each day.
Trim the tree’s stump by at least two inches on freshly cut trees. Allow it to absorb water for 24 hours before bringing it inside.



Winterizing is an important step to keep your home cozy and your bills low. These tried-and-true methods will ensure your home is sealed tight and ready for colder weather.
Whether to close o parts of your home to save energy comes down to what type of heat source you have. If you have a zonal heating system, such as a space heater or mini-split, close doors and only heat the areas you use. If you have a central-forced air heating system, leave doors open to all heated areas.

Insulating your water heater and the pipes coming out of it can save you money, especially if your water heater is outside or in a garage. Insulation kits are available at hardware stores. Be careful to keep insulation away from the pressure release valve, thermostat, flue (gas unit only) and access valves.


Insulation is like a warm sweater for your home, and air sealing is the wind breaker. Cracks, gaps and holes in a typical home can be like having a window open year-round. Seal those leaks by caulking the gaps where window trims meet the wall and window frame and adding weatherstripping around windows.
A fireplace can add ambiance to a home, but isn’t necessarily e ective at heating it. If you have a wood-burning fireplace, close the damper when your fire is extinguished. An open damper in the winter is an easy exit for the air you paid to heat. If you have a gas fireplace, please check the specifications of your unit to ensure safe operation. Some require a damper to remain permanently open so gas can vent out of the home.
Adapted from an article by Miranda Boutelle. Miranda Boutelle is the vice president of operations and customer engagement at E ciency Services Group in Oregon.



The holiday season is finally here. Some call it the most wonderful season of all. That’s because we associate it with family traditions and gathering with friends and loved ones. It’s a time of giving and spreading joy.
But giving back reminds me of the many good things we have right here in our community and why it’s so important to spread the good as far as we can, especially to the most vulnerable in our local area. I’m also reminded of how wonderful our community is and what a big impact we can have when we work together.
When you are a member of Tippah Electric Power Association, you help us spread the good throughout the year by adding a monthly donation to your utility bill. By adding your donation to Tippah County Good Samaritan Center, you will be helping local families and individuals in need. In addition to donating through your electric bill to The Good Samaritan Center, you have the option of adding My Choices Pregnancy Care Center. You can also help through donations of canned foods or specific needs, and by volunteering your time to these charities. By doing so you are helping to meet an immediate, critical need, but just as importantly, you are telling this person the community cares. If you are interested please contact these charities by phone or their Facebook page.


















Tippah EPA was able to assist the Tippah County Good Samaritan Center in acquiring a donation of $15,000 from Tennessee Valley Authority (TVA). This donation was provided by TVA Community Cares Fund. TVA matched individual donations received throughout the year by Tippah County Good Samaritan Center. Since this TVA program began in April 2020, the Community Cares Fund has helped over 600 charitable organizations throughout the Tennessee Valley region.
We like to say that the core of our cooperative is “community first”. It defines who we are as an organization. When we first brought electricity to this community in 1938, the quality of life improved. But other things also need to be addressed, and through the years, this co-op has been at the forefront of bringing improvements to the quality of life in this community. It’s why
we were so excited to provide high-speed internet by creating TEPAConnect.
To date, we have provided quality high-speed internet to over 4,300 homes, schools, and businesses. We have been able to help residential customers take part in such programs as A ordable Connectivity Program (ACP) and Lifeline which provides monthly assistance to our residential internet subscribers. Through this opportunity, we have made a substantial impact to our community through area job opportunities, improving access to online education and helped businesses grow. This shows that businesses in our community, over time, can collectively make a big impact.
As a local cooperative, we have a stake in this community. It’s why we support local organizations like the Tippah County Good Samaritan and My Choices. We hope you will think of Tippah EPA as more than your energy provider, but also as a catalyst for good in our community.
I hope all our members have a joyous holiday season. May it be merry and bright!
by Tim Smith General Manager1 box (1 lb, 2.3 oz) Betty Crocker™ fudge brownie mix, Milk Chocolate recipe

2⁄3 cup vegetable oil
¼ cup water

4 eggs
½ cup packed brown sugar
½ cup light corn syrup























1 ½ tsps vanilla



¼ cup butter, melted
2 cups chopped pecans
Heat oven to 350°F. Line a 9-inch square pan with foil, leaving two inches of foil overhanging at two opposite sides of pan; spray foil with cooking spray.
In medium bowl, stir brownie mix, oil, water and two of the eggs with a spoon until well blended. Spread batter in 9-inch square pan. Bake for 25 minutes.
In large bowl, stir brown sugar, corn syrup, vanilla, melted butter, and remaining two eggs with a whisk. Stir in pecans. Pour over partially baked brownie base.
Bake for 25 to 30 minutes, or until topping is set. Cool completely in pan on cooling rack. Refrigerate for two hours. Use foil to lift from pan. Cut into 4 rows by 4 rows.
1 box yellow cake mix
2 cans slices peaches in heavy syrup
2 tbsp ground cinnamon
½ cup brown sugar
1 ½ sticks of butter cut into thin slabs
Preheat oven to 350 degrees. Pour peaches into a greased 9” x 13” baking dish. Sprinkle cinnamon and brown sugar over the top of peaches. Pour dry cake mix over peaches.
Place slabs of butter, evenly spread out, on top of cake mix.
Bake at 350 degrees for 50-60 minutes.


THURSDAY, DEC. 8
5:30 P.M.

Tippah Electric Power Association will be closed Dec. 23 and Dec. 26 for Christmas, and Dec. 30 and Jan. 2 for New Year’s Day.
Call 662-837-8139 or use the TEPA Mobile app to report a power outage or emergency. Servicemen are on call.



A tradition was started several years ago at Tippah EPA, by former O ce Manager Brenda Storey, where area daycare centers would bring trick-or-treaters to our o ce for Halloween goodies. It has steadily grown in numbers, with children coming in droves excited about what treats are in store for them. We have been visited by superheros, princesses, cowboys, unicorns and everything else imaginable. One child even dressed up as his dad who is a lineman at Tippah EPA.





Some local daycare centers are close by and walk to our o ce. While others, who are further away, we obilge by making deliveries to those tiny ones who are waiting in anticipation.

The yearly tradition does take a lot of work on the part of our employees. Tippah EPA employees start weeks ahead of time planning, counting and making treat bags for those excited trick-or-treaters. Even though our employees put in so much work to make it happen, once we are able to see the excitement through the eyes of the children, it all becomes worth it. Hence becoming “Our Favorite Day of the Year.”






Lifeline is a federal program dedicated to making phone and internet service more a ordable for low-income households. This benefit provides eligible consumers with a monthly discount of up to $9.25. Check online at https://www.lifelinesupport.org/get-started to see if you qualify.



The A ordable Connectivity Program is a FCC benefit program that helps ensure that households can a ord the broadband they need for work, school, healthcare, and more.
The benefit provides a discount of up to $30 per month toward internet service for eligible households. Check online at https://www.fcc.gov/acp to see if you qualify.
If you have any questions about these programs, please call the TEPAConnect office at 662-587-9055.











































We all have our favorite season. Some people love crisp, cool weather, and bundling up under a favorite blanket, while others prefer the warm temperatures summer brings and all fun outdoor activities that go with it. But there’s one thing we can all agree on: high winter bills are never fun. Your electric co-op is here to help you find ways to manage your home energy use and keep winter bills in check.

Mind the thermostat. This is one of the easiest ways to manage your home energy use. We recommend setting your thermostat to 68 degrees (or lower) when you’re home. When you’re sleeping or away for an extended period of time, try setting it between 58 and 62 degrees; there’s no need to heat your home when you’re away, or sleeping and less active.

Button up your home. The Department of Energy estimates that air leaks account for 24% to 40% of the energy used for heating and cooling a home. Caulking and weather stripping around windows and doors are simple, cost-e ective ways to increase comfort and save energy. If you can feel drafts while standing near a window or door, it likely needs to be sealed.

Use window coverings wisely. Open blinds, drapes, or other window coverings during the day to allow natural sunlight in to warm your home. Close them at night to keep the cold, drafty air out. If you feel cold air around windows, consider hanging curtains or drapes in a thicker material; heavier window coverings can make a significant di erence in blocking cold outdoor air.
Consider your approach to appliance use. When combined, appliances and electronics account for a significant chunk of our home energy use, so assess how e ciently you’re using them. For example, if you’re running the dishwasher or clothes washer, only wash full loads. Look for electronic devices that consume energy even when they’re not in use, like phone chargers or game consoles. Every little bit helps, so unplug them to save energy.
Think outside the box. If you’re still feeling chilly at home, think of other ways to warm up — beyond dialing up the thermostat. Add layers of clothing, wear thick socks, and bundle up under blankets. You can even add layers to your home! If you have hard-surface flooring, consider purchasing an area rug to block cold air that leaks in through the floor.
Abby Berry writes on consumer and cooperative a airs for the National Rural Electric Cooperative Association.

Alex Swanagan wanted to pitch in for his community and create something that would help its youth build character.
That community is Hollandale in the Delta. What he did was help create a pee wee youth football program 13 years ago that he leads today.

Swanagan, 35, works as a serviceman/journeyman lineman for Twin County Electric Power Association.

When he’s not working or spending time with his wife and 5 kids, he’s on a practice or game field coaching kids.
“Work is from 8 a.m. to 5 p.m., unless I’m out on a storm call, and then practice usually starts just after 5 p.m. or 5:30 p.m. and ends at 7:30 p.m. The time with family just blends in after that when it can,” Swanagan said laughing.



His team is the Hollandale Blue Devils. His program consists of kids from ages 6 to 12.







“We formed the team because we had baseball and basketball out here in Hollandale but not football. And kids need things to do,” Swanagan said.
When the program started in 2009, 65 kids came out to join the team.
This year, Swanagan has 42 kids who make up the Hollandale Blue Devils.
The schedule of the team is a by-the-book typical football schedule.
“We practice on Sundays, Mondays, Tuesdays, Wednesdays, and Thursdays. We play games starting at 10 a.m. on Saturdays,” Swanagan said.
There’s a break on Fridays, so the community can come together to watch high school football.
Alex is a great example of a leader who exudes one of the guiding principles of cooperatives — Concern for Community. We are so proud of Alex and the young boys he coaches and mentors.
The team has an 8-game schedule, playo s, and a championship game dubbed ‘The Super Bowl.”
The Blue Devils compete against 11 other pee wee football programs around the Delta that make up the North Mississippi Youth Football Association, where Swanagan is also a commissioner.







“We travel to play teams in Tchula, Greenville, Tunica, and Clarksdale,” he said.
Swanagan, who grew up in and still lives in Hollandale, has utilized his background as a high school football player at Simmons High School to coach the team.
Although Swanagan didn’t play football in college, he’s had Blue Devils he coached take the field at The University of Southern Mississippi, Mississippi Valley State, and Morehead State University.
Swanagan said that Blue Devils going on to play college football is a special outcome, but that’s not why he coaches his kids.
“Playing football at that age teaches kids life lessons. They learn that there’s things out there bigger than football. They learn to work together for a common goal. Football teaches them discipline, and it builds character,” he said.
Swanagan has worked for Twin County for 12 years and said he loves his job.
“I really love it. You have to be a people person to do it, and you have to love working outdoors,” Swanagan said.
Twin County has been supportive of Swanagan, his commitment to the team, and the team itself.
Twin County has made donations to the team and helped pay for uniforms.
“Alex is a great example of a leader who exudes one of the guiding principles of cooperatives — Concern for Community. We are so proud of Alex and the young boys he coaches and mentors,” said Twin County General Manager Tim Perkins.
Swanagan said he loves watching the boys he coaches when they become high school students.
“They all wind up playing high school football. I enjoy seeing what they overcome and what benefits they get from playing. Our kids have won state titles. I think our program is working.”
Have you ever received your energy bill and thought, “I wonder which appliances in my home are using the most energy?” Don’t worry – you’re not alone. A few years ago, after being away for a somewhat lengthy trip, I arrived home to a typical energy bill. I was surprised because I expected a lower bill after being away from home. This led me to an enlightening journey in search for answers.
My first set of answers came from browsing the Energy Information Administration’s (EIA) website, specifically the Residential Energy Consumption Survey. According to EIA, a typical U.S. home spends more than $2,000 annually on energy bills, and on average, more than half of household energy consumption is for just two energy end uses: space heating and air conditioning. Seeing this, I understood the importance of adjusting my thermostat while I’m away because it truly makes a di erence on our monthly bills.
I also learned that water heaters tend to be the third largest energy user at 13%, followed by lighting, which usually accounts for about 12.5% of the average energy bill.
Once I understood the factors driving my energy consumption, I was able to control them and save money by using helpful devices like smart thermostats, water heater controllers, and smart power strips.


Several factors a ect the amount of energy a household uses, including geographic location and climate, the number of people in the home, the type of home, and its physical characteristics. The e ciency of energyconsuming devices and the amount of time they are used also impact home energy consumption.

In addition to the steps noted below, consider using real-time energy monitors to help identify faulty appliances or other problems like a broken water heater that runs unnoticed for extended periods of time, leading to high energy bills.

With a little extra attention to how you use energy in your home, you’ll be well on your way to a path of energy savings — and lower energy bills.













































We all have our favorite season. Some people love crisp, cool weather, and bundling up under a favorite blanket, while others prefer the warm temperatures summer brings and all fun outdoor activities that go with it. But there’s one thing we can all agree on: high winter bills are never fun. Your electric co-op is here to help you find ways to manage your home energy use and keep winter bills in check.


Mind the thermostat. This is one of the easiest ways to manage your home energy use. We recommend setting your thermostat to 68 degrees (or lower) when you’re home. When you’re sleeping or away for an extended period of time, try setting it between 58 and 62 degrees; there’s no need to heat your home when you’re away, or sleeping and less active.
Button up your home. The Department of Energy estimates that air leaks account for 24% to 40% of the energy used for heating and cooling a home. Caulking and weather stripping around windows and doors are simple, cost-e ective ways to increase comfort and save energy. If you can feel drafts while standing near a window or door, it likely needs to be sealed.
Use window coverings wisely. Open blinds, drapes, or other window coverings during the day to allow natural sunlight in to warm your home. Close them at night to keep the cold, drafty air out. If you feel cold air around windows, consider hanging curtains or drapes in a thicker material; heavier window coverings can make a significant di erence in blocking cold outdoor air.
Consider your approach to appliance use. When combined, appliances and electronics account for a significant chunk of our home energy use, so assess how e ciently you’re using them. For example, if you’re running the dishwasher or clothes washer, only wash full loads. Look for electronic devices that consume energy even when they’re not in use, like phone chargers or game consoles. Every little bit helps, so unplug them to save energy.
Think outside the box. If you’re still feeling chilly at home, think of other ways to warm up — beyond dialing up the thermostat. Add layers of clothing, wear thick socks, and bundle up under blankets. You can even add layers to your home! If you have hard-surface flooring, consider purchasing an area rug to block cold air that leaks in through the floor.
Abby Berry writes on consumer and cooperative a airs for the National Rural Electric Cooperative Association.


 by Miranda Boutelle
by Miranda Boutelle
Winterizing is an important step to keep your home cozy and your bills low. These tried-and-true methods will ensure your home is sealed tight and ready for colder weather. I’ve also included tips that address common misconceptions.

You can raise the water temperature inside your home’s water pipes by 2 to 4 degrees by insulating, according to the U.S. Department of Energy (DOE). Insulating allows you to turn down the heat on your water heater, saving energy and money.
Start by insulating the pipes coming out of your water heater. If you have a gas water heater, keep pipe insulation at least 6 inches away from the flue. Insulate hot and cold water lines. The latter can prevent condensation and freezing pipes. Insulating your water heater can save 7% to 16% on water-heating costs, DOE says. Insulation kits are available at hardware stores. Don’t obstruct the pressure relief valve, thermostats, or access valves.
Air sealing and insulation are a great combination for minimizing home energy use. Insulation is like a warm sweater for your home, and air sealing is the wind breaker. All the cracks, gaps, and holes in a typical home can be like having a window open yearround. Air sealing eliminates those leaks. It can be done as a do-it-yourself project, or by a professional.

How can I keep my home warm while saving on my electric bill this winter?
Windows can be a source of drafts and wasted energy. Close windows tightly.
Add weatherstripping around windows to prevent warm air from escaping your home and caulk the gaps where the window trim meets the wall and the window frame. Add curtains to make the room feel warmer.
Storm windows are a lower-cost option for upgrading single-pane windows. They are available with low-emissivity coatings, which insulate better, and are available for installation either from the inside or outside of the window.
Through the years, I have heard a lot of debate about closing off rooms or parts of the home to save energy.
Best practices come down to the type of heat source. If you have a zonal heating system, where individual areas are controlled separately, you can close doors and only heat the areas you use. Examples of zonal systems are wall heaters, baseboard heat, hydronic radiant heat, radiators, and ductless heat pumps, also called mini-splits.
Keep areas with plumbing or water lines warm enough so pipes do not freeze.

If you have a central forced-air heating system, leave doors open to all heated areas. Closing doors and/or register dampers forces the system to work harder, uses more energy, and can shorten the life of heating equipment.

When I was little, my dad told me it was too cold to have a fire. I remember thinking that made no sense, but he was right.
We had an open, wood-burning fireplace — not a wood stove. A fireplace can draw the warm air out of the house, cooling it down, or causing your heating system to use more energy.

Your fireplace adds ambience to your home, but isn’t necessarily effective at heating it. If you have a wood-burning fireplace, close the damper when your fire is extinguished. An open damper in the winter is an easy exit for the air you paid to heat.
Adding tempered glass doors to a wood-burning fireplace can create an extra buffer between the cold outside and a cozy living space.
Some gas fireplaces require a damper to remain permanently open so gas can vent out of the home. Check the specifications of your unit to ensure safe operation.
Maintaining a clean filter in your furnace is one of the best ways to keep it running efficiently and prevent costly repairs. Check your furnace or ductless heat pump filter monthly during peak heating season.
Have you ever received your energy bill and thought, “I wonder which appliances in my home are using the most energy?” Don’t worry – you’re not alone. A few years ago, after being away for a somewhat lengthy trip, I arrived home to a typical energy bill. I was surprised because I expected a lower bill after being away from home. This led me to an enlightening journey in search for answers.
My first set of answers came from browsing the Energy Information Administration’s (EIA) website, specifically the Residential Energy Consumption Survey. According to EIA, a typical U.S. home spends more than $2,000 annually on energy bills, and on average, more than half of household energy consumption is for just two energy end uses: space heating and air conditioning. Seeing this, I understood the importance of adjusting my thermostat while I’m away because it truly makes a di erence on our monthly bills.
I also learned that water heaters tend to be the third largest energy user at 13%, followed by lighting, which usually accounts for about 12.5% of the average energy bill.
Once I understood the factors driving my energy consumption, I was able to control them and save money by using helpful devices like smart thermostats, water heater controllers, and smart power strips.
Several factors a ect the amount of energy a household uses, including geographic location and climate, the number of people in the home, the type of home, and its physical characteristics. The e ciency of energyconsuming devices and the amount of time they are used also impact home energy consumption.
In addition to the steps noted below, consider using real-time energy monitors to help identify faulty appliances or other problems like a broken water heater that runs unnoticed for extended periods of time, leading to high energy bills.


With a little extra attention to how you use energy in your home, you’ll be well on your way to a path of energy savings — and lower energy bills.

Use ENERGY STAR®-rated appliances and devices. Use appliances with e ciency in mind. Only wash full loads of clothes or dishes. When possible, cook with smaller, countertop appliances.

Replace old, ine cient equipment. If your air conditioner, or water heater is more than 10 years old, it is likely using a lot more energy than necessary. A newer model will save you money in the long run and help you avoid an inconvenient breakdown.
Set your thermostat accordingly to scale back heating or cooling when asleep or away. In the home and active, the Department of Energy recommends setting it to 78 degrees in the summer and 68 degrees in the winter.
Use energy e cient LED bulbs. They use 75% less energy than incandescent bulbs and last 25 times longer. Plug electronics into a smart power strip, which allows you to designate “always on” for devices that need to maintain network connection, while cutting power from devices like speakers and TVs when they are not in use.
To save energy and reduce your monthly bill, the following tips can help:
I cannot wait for this year to be over. This has been a tough year for me, both professionally and personally, and I’m looking for brighter and better days in 2023.
The year started o with the loss of a couple of key employees, one to retirement, and the other to another job. Even this magazine had its share of problems, to the point that some months I was not certain we would be able to get it published.
We have had to deal with paper shortages (apparently a strike in Finland helped cripple the world’s paper supply), skyrocketing paper prices, and then our printer canceled our contract with little notice. (Something about being too big for their business model.)
For
My wife had a much-needed knee replacement, which left me as a “care giver,” not exactly my strong suit. Oh, and for those of you who think your children will be helpful — ours fled the house like rats from a sinking ship. (I have been in contact with my attorney, and we are making some changes in the will.)
If you ever find yourself with a strong desire to take a pillow and smother the one that you love, take a deep breath, and make a Krystal run. I promise you will feel much better.
ahead.
This year’s runaway inflation has wreaked havoc on our operating budget, much like it has done to just about every business in the country. Luckily, I have a great sta and they worked hard to help us navigate these many hiccups in 2022. Some stepped up to take promotions, while others added to their job duties until we could get new personnel in place. I am proud of them and the job they do. After this year, I have no doubt that I have the best cooperative statewide sta in the country. Personally, the year started o with a hospital stay and two stents for my heart. I now have a diet that basically is, “if it tastes good, spit it out.” I must confess, I cheat. Between my wife and my administrative assistant, I feel like I am under 24-hour surveillance. I found myself slipping out the back door of my o ce and making a stealth run to a nearby Krystal. After that, I would drive to Ridgeland City Park and eat the small burgers in solitude before disposing of the evidence in a park trash can. It was exhilarating to be living so dangerously. I have also dealt with the loss of some close family members, including my father. My mom recently moved in with us, after a long hospital stay, and we are working to rebuild her strength so that she can return home soon.
The year did have some bright spots, especially during the month of May. My two oldest children, Michael and Katlyne, both graduated from The University of Southern Mississippi. I shot my lowest score for 18 holes of golf. Melissa and I celebrated our 33rd wedding anniversary.
Everyone has problems. Some of you have had a bad 2022, some of you, after really thinking about it, realize maybe it wasn’t as bad as you thought. I have always believed that whatever problems I have, they pale in comparison to the problems of others. I am blessed, even though sometimes, I forget that I am.
As the year ends and we celebrate Christmas, let us remember that with Christmas comes hope. It’s not just about food, fellowship, and presents. For Christians, Christmas should remind us that God sent us a savior, not to just give us hope for this life, but hope for what lies ahead. Yes, we will encounter tough times, but we do not have to endure them alone. He will be with us.
So, I hope everyone has a Merry Christmas and a much better 2023!
by Michael Callahan Executive Vice President/CEO Electric Cooperatives of Mississippi

Sitting in a tree stand up in a tall White Oak, that whitetail buck deer tipping through the slough so slow.
The pop of a jug when that blue cat takes the bait, being out on the Tenn-Tom River at night, real late.
A plump fox squirrel sitting high up in a Pine, flicking her tail as the cur dog tries to find her before she can hide.
Ole Tom turkey gobbling across the creek, hiding in a brush top hoping he struts by me.
Throwing a frog across the lily pads and grass, setting the hook on a 5-pound bass.
Being in the woods as the morning sun shines bright, or on the riverbanks, the moon my only light.

Way out yonder with all of God’s Dixieland delights.
by Tia Greene, a resident of Columbia, and a member of 4-County Electric.

What’s Mississippi to you? What do you treasure most about life in our state? Send your brief thoughts to Today in Mississippi, news@ecm.coop or mail to P.O. Box 3300, Ridgeland, MS 39158
Submit your beautiful digital photo of life in Mississippi to Today in Mississippi, news@ecm.coop

Christians, Christmas should remind us that God sent us a savior, not to just give us hope for this life, but hope for what lies
Yes, we will encounter tough times, but we do not have to endure them alone. He will be with us.A Walker hound treeing in the river bottom, his long bawl bark telling me he’s got ‘em.















